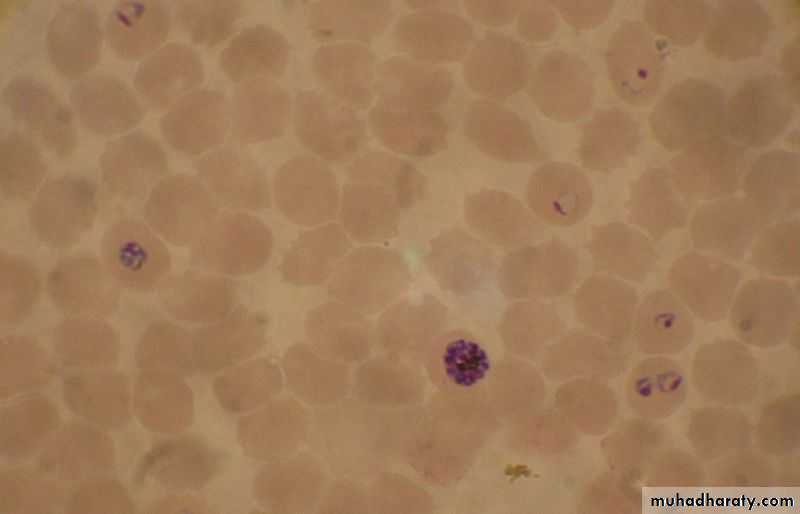

Panoramain medicine 7
د. حسين محمد جمعهاختصاصي الامراض الباطنة
البورد العربي
كلية طب الموصل
2012
A low ratio of ALT:AST suggests non-alcoholic steatohepatitis.
An AST level greater than the ALT level suggests alcohol related liver disease.AST/ALT ratio in these patients is typically 2:1 or more.
When a patient's history is not reliable, increased GGT levels with normal ALP levels and macrocytosis make alcohol induced liver damage more likely.
Alanine aminotransferase (ALT)
is considered more specific for hepatocellular injury because it is predominantly represented in the liver, with low concentrations in other tissues.Aspartate aminotransferase (AST) is also expressed in the heart, skeletal muscle, and red blood cells.(>in alcohol ,affect the mentioned organs also)
Delayed relaxation phase of deep tendon reflexes
Differential DiagnosisHypothyroidism
Neurosyphilis, parkinsonism, pernicious anemia
sarcoidosis, myasthenia gravis, schizophrenia
diabetes mellitus,glucose administration
sprue, medications (propranolol, procainamide, reserpine, potassium), hypothermia, leg edema, normal puerperium, female sex, age.
High serum ferritin levels and, more importantly,
a transferrin saturation index (serum iron/total iron binding capacity) larger than 45%
strongly suggest haemochromatosis.
Cigarette smoking:
two to four times more likely to develop coronary heart disease than non-smokers and they have double the risk for stroke. The mechanisms are complex and likely multifactorial and result inendothelial dysfunction and a relatively hypercoagulable state.
It is known that after smokers give up smoking, their risk of mortality and future cardiac events declines, although whether cardiovascular risk for former smokers ever reaches that of never smokers, researchers found that the smoking-associated inflammatory response subsides within 5 years after smoking cessation, suggesting that the cardiovascular risk subsides gradually with reduced exposure.
A number of studies have shown that smoking increases the risk of tuberculosis two- to fivefold. A study in India showed that tuberculosis is the most common cause of death in smokers. This is probably due to suppression of alveolar macrophages by substances in the cigarette smoke.
A sputum smear test
In about 50% of patients with pulmonary tuberculosis the sputum smear test will be negative. This is because over10 000 bacteria per ml of sputum are needed to give a positive smear. Increasingly in the white population of the UK a positive smear results from an environmental mycobacterium such as M kansasii or M avium, not M tuberculosis. So a sputum smear test cannot definitively confirm the diagnosis of tuberculosis.
HIV infection is by far the strongest risk factor for tuberculosis: it increases risk by about
100-fold.
jejunal bypass surgery, which increases risk by about 20-fold for reasons we don't understand.
Diabetes and smoking both increase risk by between two- and fivefold (by depressing host immunity).
Being tall and thin increases risk by about 1.3- to 1.5-fold
The new gamma interferon blood tests will help to distinguish between a skin test rendered positive by BCG vaccination alone and one rendered positive by genuine infection with M tuberculosis because the blood tests use antigens specific to the tuberculosis bacteria and not to the BCG vaccine
What are the symptoms of heart attack in women and how is heart attack diagnosed?
Women are more likely to encounter delays in establishing the diagnosis of heart attack than men. This is in part because women tend to seek medical care later than men, and in part because diagnosing heart attacks in women can sometimes be more difficult than diagnosing heart attacks in men. Because Women are more likely than men to have atypical heart attack symptoms such as:• Women are more likely than men to have atypical heart attack symptoms such as:
• neck and shoulder pain,• Abdominal pain ,
• nausea,
• vomiting,
• fatigue, and
• Shortness of breath.
Silent heart attacks (heart attacks with little or no symptoms) are more common among women than among men.
Women have a
1. higher occurrence than men of chest pain that is not caused by heart disease, for example chest pain from spasm of the esophagus. Women are2. less likely than men to have the typical findings on the ECG that are necessary to diagnose a heart attack quickly.Women are
3. more likely than men to have angina that is caused by spasm of the coronary arteries or caused by disease of the smallest blood vessels (microvasculature disease). Coronary angiograms that are considered the most reliable tests for CAD will reveal normal coronary arteries and therefore cannot be used to diagnose either of these two conditions.
Women are more likely to have misleading, or 4."false positive" noninvasive tests for CAD than men.Because of the atypical nature of symptoms and the occasional difficulties in diagnosing heart attacks in women, women are
5. less likely to receive aggressive thrombolytic therapy or coronary angioplasty, and are more likely to receive it later than men.
Women also are
6. less likely to be admitted to a coronary care unit.
Injectable anticoagulants comprise:
• Heparins
• Heparinoids
• Fondaparinux
• Hirudins.
The mechanism for the anticoagulant activity of unfractionated heparin is binding to antithrombin III, which catalyses the inactivation of factors
IIa, IXa, Xa, and XIIa. Thrombin and factor Xa are most sensitive to the effects of heparin.
Low molecular weight heparins exert their effects almost entirely through inhibiting factor Xa.
Heparinoids, such as danaparoid, have similar activity to that of low molecular weight heparins, but contain no heparin or heparin fragments. Danaparoid is indicated only for treating venous thromboembolism in patients with a history of heparin induced thrombocytopenia.
Fondaparinux is a synthetic pentasaccharide that selectively inhibits factor Xa. can be administered daily without laboratory monitoring.is licensed for prophylaxis of venous thromboembolism in medical patients and in patients undergoing major orthopaedic surgery of the legs. It is also licensed for treating deep vein thrombosis and for pulmonary embolism.
Hirudins are polypeptides that inhibit factor IIa (prothrombin)
and can therefore be classed as direct thrombin inhibitors. Two products are available in the UK:• Lepirudin is licensed for anticoagulation of people with heparin induced thrombocytopenia type II
• Bivalirudin is licensed for patients undergoing percutaneous coronary intervention.
Pharmacokinetics of heparins
At usual intravenous doses the half life of unfractionated heparin is 45-60 minutes. The bioavailability of subcutaneous unfractionated heparin is less than 50%.Low molecular weight heparins have a half life of about four hours. They are 90-100% bioavailable after subcutaneous injection.
There are five forms of malaria which cause disease in humans:
• Plasmodium falciparum (common)
• Plasmodium vivax (common)
• Plasmodium ovale
• Plasmodium malariae
• Plasmodium knowlesi.
Drugs that can induce parkinsonism
• Old antipsychotics (haloperidol)• New antipsychotics (olanzapine)
• Anti-nausea agents (prochlorperazine)
• Antihistamines (cinnarizine).
Acute pulmonary emboli typically present in four main ways
1. Circulatory collapse in a previously well patient(5%): hypotension ± loss of consciousness. This is usually due to massive pulmonary embolism causing acute right heart failure.2. Pulmonary infarction syndrome (60%): typically presents with pleuritic pain, with or without haemoptysis. Localising signs, eg a pleural rub, may also be present.
3. Isolated dyspnoea (25%): acute breathlessness without haemorrhage or circulatory collapse. This typically presents with sudden onset shortness of breath in the presence of risk factors for pulmonary embolism.
4. Collapse, poor reserve (10%): classically in an elderly patient with limited cardiorespiratory reserve; a small pulmonary embolism can be catastrophic.
British Thoracic Society pre-test probability scor
A standard assessment of pre-test clinical probability include:
A
Patient has clinical features compatible with pulmonary embolism (raised respiratory rate, ± haemoptysis, ± pleuritic chest pain)
Plus two other factors:
1
Absence of another reasonable clinical explanation
2
Presence of a major risk factor
A plus 1 and 2
High pre-test clinical probability
A plus 1 or 2
Intermediate pre-test clinical probability
A alone
Low pre-test clinical probability
The pre-test clinical probability score should always be used with the D-dimer test .
A low pre-test clinical probability score, combined with a negative D-dimer test has about a 90% sensitivity at excluding pulmonary embolism.What is shock and why is it important?
Shock is a clinical state with diverse causes that occurs as a consequence of inadequate tissue perfusion, leading to an insufficient oxygen supply for the patient's metabolic requirements. This imbalance results in tissue hypoxia and lactic acidosis, which, if not promptly reversed, leads to progressive cellular injury, multiple organ failure, and death.Shock is an important cause of morbidity, accounting for 34% of admissions to the intensive care unit, with mortality rates of 50-60% for septic shock and 60-80% for cardiogenic shock.
Normally, only 20-30% of the delivered oxygen is extracted by the tissues (oxygen extraction ratio).
The remaining oxygen returns to the venous circulation and can be measured using a central venous catheter (central venous oxygen saturation) or in the pulmonary artery using a pulmonary artery catheter (mixed venous oxygen saturation).
Generally, shock is associated with a fall in oxygen delivery secondary to
• a reduction in cardiac output,• arterial oxygen saturation, or
• haemoglobin levels.
To meet their oxygen requirements and maintain a constant oxygen consumption, the tissues adapt to the lower levels of oxygen delivered to the tissues by extracting a larger fraction of the delivered oxygen.
Tissues, however, cannot extract more than 60% of the oxygen delivered.
Causes of cardiogenic shock
CategoriesCauses
Myocardial diseases
Myocardial infarction or ischaemia
Cardiomyopathies
Myocarditis
Arrhythmias
Ventricular more commonly than supraventricular
Valvular diseases
Acute aortic regurgitation
Critical aortic stenosis
Mitral regurgitation caused by rupture of a papillary muscle or chordae tendineae
Ventricular septal defects
Obstructive
Pulmonary embolism
Tension pneumothorax
Constrictive pericarditis
Pericardial tamponade
The most frequent cause of cardiogenic shock is acute myocardial infarction( loss of more than 40% of the left ventricle). Cardiogenic shock occurs in about:
5-15% of patients with ST elevation MI.
2.5% of patients with non-ST MI.
Patients who present with cardiogenic shock have a higher in-hospital mortality rate than those who develop cardiogenic shock later in their admission (75% versus 56%), but have a similar response to emergency revascularisation.
Intra-arterial monitoring to obtain arterial blood samples for gases, acid-base balance, and arterial lactate, and to monitor blood pressure and titrate vasoactive drugs
Dopamine is a natural catecholamine formed by the decarboxylation of 3,4-dihydroxyphenylalanine (DOPA). It is a precursor to norepinephrine in noradrenergic nerves and is also a neurotransmitter in certain areas of the CNS especially in the nigrostriatal tract, and in a few peripheral sympathetic nerves. It is released from the hypothalamus and aids with bodily functions such as movement, cognitive functions, motivation and pleasure.
Dopamine produces positive chronotropic and inotropic effects. This is accomplished directly by exerting an agonist action on beta-adrenoceptors and indirectly by causing release of norepinephrine from storage sites in sympathetic nerve endings.
At low rates of infusion (0.5-2 mcg/kg/min) dopamine causes vasodilation that is presumed to be due to a specific agonist action on dopamine receptors (distinct from alpha and beta adrenoceptors) in the renal, mesenteric, coronary, and intracerebral vascular beds.
The vasodilation in these vascular beds is accompanied by increased glomerular filtration rate, renal blood flow, sodium excretion, and urine flow. Hypotension sometimes occurs.
At intermediate rates of infusion
(2-10 mcg/kg/min) dopamine acts to stimulate the beta1-adrenoceptors, resulting in improved myocardial contractility, increased SA rate and enhanced impulse conduction in the heart. There is little, if any, stimulation of the beta2-adrenoceptors (peripheral vasodilation). Dopamine causes less increase in myocardial oxygen consumption than isoproterenol, and its use is not usually associated with a tachyarrhythmia.At higher rates of infusion (10-20 mcg/kg/min) there is some effect on alpha-adrenoceptors, with consequent vasoconstrictor effects and a rise in blood pressure. The vasoconstrictor effects are first seen in the skeletal muscle vascular beds, but with increasing doses they are also evident in the renal and mesenteric vessels.
At very high rates of infusion (above 20 mcg/kg/min), stimulation of alpha-adrenoceptors predominates and vasoconstriction may compromise the circulation of the limbs and override the dopaminergic effects of dopamine, reversing renaldilation and natriuresis
Do NOT add DOPAMINE Injection to Sodium Bicarbonate or other alkaline intravenous solutions, since the drug is inactivated in alkaline solution.
Dobutamine is considered a direct beta1-adrenergic agonist. It also has mild beta2- and alpha1-adrenergic effects at therapeutic doses. These effects tend to balance one another and cause little direct effect on the systemic vasculature. In contrast to dopamine, dobutamine does not cause the release of norepinephrine. It has relatively mild chronotropic, arrhythmogenic, and vasodilative effects.
Cerebral infarction causes 85% of strokes;
cerebral haemorrhage causes 15%.Intracerebral haemorrhages - about 12-13%
Subarachnoid haemorrhages - about 2-3%.
Stroke is an emergency and you should see patients quickly. This applies both to acute treatment and to secondary prevention.
Thrombolysis is only licensed for use within three hours of onset
Stroke is the third most common cause of death in the UK.
Ten to twenty percent of strokes are fatal.a third of patients remain disabled.
Morning headache is not a typical feature of migraine with aura. Morning headache may indicate
1. increased intracranial pressure,
2. nocturnal carbon dioxide retention,3. nocturnal hypoglycaemia.
• A. Cardiovascular syncope
• 1. Reflex - Vasovagal Syncope (Vasodepressor) a.Carotid sinus cardioinhibitory, vasodepressor central b.Vasovagal cough, micturition defecation, post-prandial valsalva, sneeze
• 2. Orthostatic a.Dehydration / Blood Loss: Diuretic drugs: thiazides, furosemide, Zaroxolyn, etc.b.Autonomic insufficiency :Autonomic nervous system dysfunction: diabetic, alcoholic, Shy Drager Syndrome (degenerative CNS)c. Sympathetic nervous system blocker drugs: methyldopa, prazosin, guanethidine, phenothiazines, tricyclicsd. Adrenal Insufficiency e. Vasodilator drugs f. Idiopathic
syncope
3.Mechanical (Obstructive) a.Aortic Stenosis b.Hypertrophic cardiomyopathy c.Pulmonary Embolism, HTN, Stenosis d.Aortic Dissection e.Myocardial Infarction
4. Electrical (arrhythmia cardiac syncope) a. AV Block b. Sick Sinus Syndrome c. Arrhythmia (Ventricular vs. Supra-) d. Long QT syndrome
• B. Neurologic syncope
• Transient Ischemic Attack (TIA)• Seizure
• Takayatsu (Giant Cell) Arteritis
• Intermittent Pressure Hydrocephalus
• Psychiatric - panic disorders, depression , hysteria
• Subclavian Steel Syndrome
• Vertebrobasilar insufficiency
• C. Metabolic syncope
• Hypoglycemia syncope
• Hypoxia syncope
• Shock
• Hyperventilation
• Anemia
• Alcoholic
• D. Idiopathic /Unexplained (~50%)
• Diagnosing Syncope
• For heart rhythm-related causes, an electrocardiogram (ECG) recorded during the fainting episode is considered to be the "gold standard," that is, the best possible way to tell if the syncope is caused by a heart rhythm problem.
• Tests for determining the cause of syncope
• ECG: to check for arrhythmia, cardiac cause.
• Holter monitor: used for continuous monitoring on an in-patient basis for 24 to 48 hours, or for slightly longer periods of time on an outpatient basis.
External loop recorder: A device that monitors heart rhythm and rate for up to one month. During this test, the patient wears a device on the wrist or around the waist.
After waking from a fainting episode, the patient presses a button on the device to make a recording of the heart activity during the fainting episode. Because external loop recorders can be worn for longer periods of time (up to one month) than Holter monitors, they are somewhat more effective in diagnosing syncope.
Tilt table test: This procedure attempts to simulate conditions that may cause fainting. It enables a physician to gauge how blood pressure, heart rate and rhythm respond to a change in position from lying down to standing. The patient is positioned on a table, given medication, and the table is tilted by varying degrees. The patient typically is tilted for 20 to 45 minutes. If the patient does faint during this test, the simultaneous heart monitoring should show whether the faint was caused by an arrhythmia. If not, the patient may be returned to a flat position, injected with a drug that makes the heart's lower chambers contract, and then tilted again for up to 30 minutes. If this stage of the test induces a faint, again the heart monitor should indicate whether the faint is related to an abnormal heart rhythm.
Electrophysiology (EP) Study: Performed in a special lab in the hospital, this lengthy procedure attempts to reproduce an abnormal heart rhythm if it is the suspected cause of fainting. This is done by threading catheters into the heart to record the heart's own electrical impulses and to assess the response to pacing and extra beats.
Other tests: These may include an electroencephalogram (EEG), magnetic resonance imaging (MRI), an echocardiogram ("echo"), neurologic or psychiatric evaluations, depending on what the doctor suspects as the cause of the fainting.
Limitations of traditional diagnostic methods While nearly half of patients with recurrent, unexplained fainting remain undiagnosed after undergoing these tests, these methods have been, until recently, the best tools available to physicians for diagnosing the causes of syncope. The heart-monitoring methods listed above are particularly useful in diagnosing syncope that is relatively frequent, and therefore more likely to occur during testing.
Where the traditional heart-monitoring tests fall short is that they only monitor the heart for a relatively limited amount of time. Since the most difficult forms of syncope to diagnose are those that occur infrequently, the best diagnostic tool would be one that continuously monitors the heart's rhythm and rate for long periods of time — on the order of several months or more.
Now there is a new diagnostic tool available that can monitor the heart for up to 14 continuous months, making a diagnosis for recurrent, infrequent syncope much more likely.
The device is called the Medtronic Reveal® Insertable Loop Recorder. This new, state-of-the-art technology represents a breakthrough in the diagnosis of fainting. The Reveal Insertable Loop Recorder can determine if fainting is related to a heart rhythm problem in up to 94 percent of cases. Smaller than a pack of gum, the Reveal Insertable Loop Recorder is inserted just beneath the skin in the upper chest area in a brief outpatient procedure that typically takes 15 to 20 minutes.
To capture and store the electrocardiogram (ECG) as it occurred at the time of the fainting episode, a patient places a hand-held, pager-sized Activator over the Reveal Insertable Loop Recorder after waking from a fainting episode, and presses a button. A family member or friend also can be the one to place the Activator over the patient's device to save the information. It is important for the patient to keep the Activator handy at all times (clipped to the clothes or looped over a belt). Later, a physician analyzes the stored information and determines whether the fainting episode was caused by an abnormal heart rhythm. Once the physician determines this, the device is removed and either treatment is begun or the patient is referred to other specialists.
The diagnosis is clinically made on the basis of the history of typical attacks, especially in patients from the ethnic groups in which FMF is more highly prevalent. An acute phase responseis present during attacks, with high
C-reactive protein levels, an elevated white blood cell count and other markers of inflammation. In patients with a long history of attacks, monitoring therenal function is of importance in predicting chronic renal failure.
A genetic test is also available to detect mutations in the MEFV gene.
Sequencing of exons 2, 3, 5, and 10 of this gene detects an estimated 97% of all known mutations.
FMF
A specific and highly sensitive test for FMF is the "Metaraminol Provocative Test (MPT)," whereby a single 10mg infusion of Metaraminol is administered to the patient.
A positive diagnosis is made if the patient presents with a typical, albeit milder, FMF attack within 48 hours. As MPT is more sensitive than specific, it does not identify all cases of FMF. Although a positive MPT can be very useful.
The VIDAS TOXO IgG Avidity assay can be used to rule out recent Toxoplasma gondii infection. The test works by detecting how strongly IgG avidity antibodies bind to the Toxoplasma gondii antigens in the assay. IgG avidity antibodies from infections older than four months bind tightly with the antigens,
while IgG avidity antibodies from infections acquired in the past four months form weaker bonds.
FDA clears first test for recent infection with toxoplasmosis parasite.
May 19, 2011
The VIDAS TOXO IgG Avidity Assay test is for use in people who have been confirmed with the Toxoplasma gondii infection by using the VIDAS TOXO IgG II test and who are pregnant or have swollen lymph glands. The VIDAS TOXO IgG Avidity Assay test alone should not be used as a basis for clinical decisions.
The performance of the VIDAS TOXO IgG Avidity Assay has not been established for prenatal screening, for immunocompromised patients, or for cases of toxoplasmosis reinfection or relapse, and the FDA has not cleared or approved the VIDAS TOXO IgG Avidity Assay for blood or plasma donor screening.
Mean arterial pressure (MAP]
Equation: MAP = [(2 x diastolic)+systolic] / 3Diastole counts twice as much as systole because 2/3 of the cardiac cycle is spent in diastole.An MAP of about 60 is necessary to perfuse coronary arteries, brain, kidneys.Usual range: 70-110
• where PP is the pulse pressure, SP − DP
The Ambulatory Blood Pressure Monitor
Blood pressure and body fat monitoring wristwatchThe Ambulatory Blood Pressure Monitor
What is protected left main disease ? How good is the protection ?If good , why should it need another protection ?
Left main disease has special interest for the interventionist. Traditionally cardiologist have a fear to touch this lesion , as they thought a sudden occlusion within this vessel is life threatening.Later on as they gained experience it was thought we could intervene safely at least in protected left main . Subsequently it was realised this fear was largely unfounded , after all the proximal LAD is equally dangerous and we spend hours together inside an LAD ! .Now we have technology and expertise to do successful PCI any where in LM. And unfortunately , the same expertise is not applied in selecting the ideal patients who will benefit the most . LMD has become a glorified indication for PCI.
Protected LMD meant there must be a at least one graft to either LAD or circumflex . And this graft should be functional .
The presence of this graft is supposed to increase the comfort levels of the interventionist as well as the patient.
Protected left main
• Post CABG with atleast one functional graft to LAD /LCX
• ? Left main with total LAD and very good LAD collaterals from RCA /LCX
If a left main is well protected by a functional LAD graft , why should we do a PCI for left main at all ?
Double protection is waste of resource at additional risk.
Does every patient after a CABG has a high chances of developing LMD ?
What is accelerated atherosclerosis of Left main following LAD /LCX grafts ? It is true left main has high risk of accelerated atherosclerosis and it undergoes gradual obstruction once the LAD and LCX is grafted.This is due to low flow across the native left main as distal grafts maintain the flow .This is all the more likely in good bulk of patients who had undergone CABG where LMD was the indication .
Final message
A well protected left main with a good functioning graft especially to LAD most often do not require a fresh revascularisation procedure irrespective of the tightness of left main disease . Most of such patients will be candidates for medical therapy .Contrary to the popular belief , left main intervention could be confined to ” unprotected LMD rather than well protected LMD” as the potential benefits are more .Further interventional resources need not be wasted in giving second alternate protective channel for an already protected vessel !Of course it should be remembered in any given patient with protected or unprotected LMD the indication for revascualrisation is based on the severity of lesion , symptoms, LV function , residual ischemia, viability etc .
Suggestions ,comments and corrections welcome
john brownWhat do you do with an asymptomatic patient aged 71 (her mother died of sudden cardiac death at 71)…she is very high functioning and enjoying life… (unable to tolerate statins)…and normal lipid levels. ApoB <80mg/dL. but low HDL-C. Her CT calcium score is 1000 with a LAD score of 640 and L. main of 90. She has passed a nuclear stress test. Should she consider CABG/Stening/ or just medical therapy?- thx- JB
drsvenkatesan
Hi
As I can understand the your patient has a extremely good functional capacity, of course with no symptoms. (By the way why should we call her a patient ?)She has no ischemia on nuclear. There is no indication for CABG.She can be substituted with non statin drugs for her lipids.Just follow up the coronary calcium levels.
There is evidence to suggest calcium rich plaques are immune to rupture and hence acute coroanry syndromes are less common.Thanks for writing to mevenkatesan Chennai.India
Troponin is a complex of three regulatory proteins that is integral to muscle contractionin skeletal and cardiac muscle, but not smooth muscle.
Individual subunits serve different functions:
• Troponin C binds to calcium ions to produce a conformational change in TnI
• Troponin T binds to tropomyosin, interlocking them to form a troponin-tropomyosin complex
• Troponin I binds to actin in thin myofilaments to hold the troponin-tropomyosin complex in place
Troponins T and I are only found in cardiac muscle
Troponin T84% sensitivity for myocardial infarction 8 hours after onset of symptoms; 81% specificity
low specificity - 22% for unstable angina
advantages
highly sensitive for detecting myocardial ischaemia
levels may help to stratify risk afterward
Troponin I
90% sensitivity for myocardial infarction 8 hours after onset of symptoms; 95% specificity
low specificity for unstable angina - 36%
troponin T and I are present for, and remain elevated, a long time unlike CK and CK-MB, cTnT and cTnI are released for much longer with cTnI detectable in the blood for up to 5 days and cTnT for 7-10 days following MI. This allows an MI to be detected if the patient presents late
Studies have revealed that about one third of patients admitted with unstable angina, in whom MI was apparently excluded by CK and CK-MB measurement, have raised levels of cTnT and cTnI. Follow up studies have revealed that these patients are at significantly greater risk of death, subsequent MI or readmission with unstable angina than patients who did not have detectable levels cTnT or cTnI
General disadvantages elevation of cTnT or TnI is absolutely indicative of cardiac damage, but this can occur as a result of causes other than MI
e.g. myocarditis, coronary artery spasm from cocaine,
severe cardiac failure,cardiac trauma from surgery or accident, and pulmonary embolus can cause cardiac damage with an accompanying elevation .both cTnT and cTnI may be elevated in patients with chronic renal failure and indicate a higher long-term risk of death.
Myocardial infarction causes a rise and fall in cTnT or cTnI, but in renal failure the elevated levels are sustained.
failure to show a rise in cTnT or cTnI does not exclude the diagnosis of ischaemic heart disease .
Can We Identify Unstable Coronary Plaques Before They Rupture?
Intravascular ultrasound (IVUS) uncovers some predictive plaque characteristics, but clinical application of the findings is still a long way off.Comment: These investigators are the first to use ultrasound to prospectively examine nonobstructive lesion characteristics predictive of subsequent adverse cardiac events. They found that lesions with a large plaque burden, small luminal area, and thin cap are associated with the highest risk for causing later events. Although these findings are mechanistically interesting, their specificity is low, IVUS conferred procedural risk, and the appropriate therapeutic approach to these lesions is uncertain. Therefore, the strategy is presently unsuitable for clinical application.
Medical treatment, PCI, or CABG for coronary artery disease?
The three approaches should complement one another, not compete.Medical treatments of CAD have improved in the past decade because of the availability of statins, effective blood pressure lowering drugs (in particular angiotensin converting enzyme inhibitors), calcium blockers, and antiplatelet agents. 1 In addition, improvements in percutaneous coronary interventions (PCI) have revolutionised the management of high risk people with acute myocardial infarction (primary PCI and rescue PCI) and non-ST elevation myocardial infarction and unstable angina.
• BMJ 2011; 342
The use of stents, together with antiplatelet and antithrombotic treatments, has reduced procedural complications and made PCI safer.
Drug eluting stents have reduced restenosis after PCI,
although they increase late stent thrombosis, for which long term dual antiplatelet treatment is required.
Improvements in coronary artery bypass (CABG) surgery have been slow because only a few randomised controlled trials have been performed. Surgeons still debate the benefits of off-pump CABG (beating heart surgery) versus on-pump surgery, 4 and whether double internal mammary artery grafts are superior to single internal mammary grafting. Both questions are currently being evaluated in large randomised trials. 5 Given that CABG surgery is increasingly performed in older people who are at high risk of cardiac, neurological, and renal complications, it is notable that CABG surgery results are improving worldwide.
• BMJ 2011; 342
Is coronary artery bypass grafting the treatment of choice for diabetic patients with multivessel disease? Yes
In patients with angina for whom both (PCI) and (CABG) are technically feasible, overall mortality and rates of myocardial infarction are similar, but PCI is associated with a higher risk of recurrent myocardial ischaemia. The trade-off between the increased need for re-intervention after PCI and the avoidance of major surgery is generally acceptable. However, diabetes is associated with a particularly high rate of recurrence after PCI and, for patients with multivessel disease, CABG provides more durable symptom relief and a lower risk of late complications.
• BMJ 2010; 341:
Diabetes is accompanied by a tendency to aggressive atherosclerosis, and the results of myocardial revascularisation are less favourable in diabetic patients than in those without diabetes.
This makes recurrence more likely with PCI because it treats only the obstructions present at the time of the procedure whereas CABG bypasses the entire arterial segment in which the disease is most prevalent, protecting against ischaemia from lesion progression. Moreover, diabetes increases the risks of restenosis and stent thrombosis.
The primary objective of myocardial revascularisation is to relieve angina. Diabetic patients with multivessel disease face three to six times the likelihood of recurrence requiring re-intervention in the first year after PCI than after CABG and, on current evidence, a higher risk of subsequent death and myocardial infarction. PCI is an option for patients with severe angina and comorbidities that preclude surgery and for the minority in whom only PCI is technically feasible, but CABG should remain the standard of care for diabetic patients with multivessel disease.
February 10, 2011 (Los Angeles, California) — Final results of the AVERROES trial confirm that apixaban (Pfizer/Bristol-Myers Squibb), a still-investigational factor Xa inhibitor, reduced the risk for stroke and systemic embolism compared with aspirin alone without increasing major or intracranial bleeding in patients with atrial fibrillation not considered candidates for warfarin therapy.
Apixaban is one of several new agents that aim to provide an alternative to warfarin for stroke prevention in patients with atrial fibrillation. Another agent, dabigatran, recently won approval from the US Food and Drug Administration for this indication, and another, rivaroxaban
was noninferior to warfarin without an increase in bleeding in the recently reported ROCKET-AF trial.
The positive results with apixaban for atrial fibrillation in AVERROES come on the heels of disappointing recent topline results of a phase 3 trial testing this agent in high-risk patients with recent acute coronary syndrome. TheAPPRAISE-2 (Apixaban for Prevention of Acute Ischemic Safety Events) study was stopped in November 2010 when it became clear that the increase in bleeding risk in patients randomly assigned to apixaban would not be offset by a reduction in ischemic events.
A head-to-head comparison of apixaban, 5.0 mg twice daily, vs warfarin in patients with atrial fibrillation is still ongoing. That trial, called Apixaban for the Prevention of Stroke in Subjects with Atrial Fibrillation (ARISTOTLE) is expected to be presented in August. The results of that trial will determine timing for Food and Drug Administration filing, Dr. Diener said.
N Engl J Med. February 10, 2011.
Apixaban, which is currently being developed by Bristol-Myers Squibb and Pfizer, is an investigational oral factor Xa inhibitor, a new class of agents being studied for the prevention and treatment of blood clots. Apixaban is being investigated within the EXPANSE Clinical Trials Program, which is projected to include nearly 60,000 patients worldwide across multiple indications and patient populations and includes a total of nine completed or ongoing, randomized, double-blind Phase 3 trials, including AVERROES.
The apixaban Phase 3 trial program is evaluating the prevention of venous thromboembolism, prevention of stroke and other thromboembolic events in patients with atrial fibrillation, the treatment of venous thromboembolism and secondary prevention of cardiovascular events in patients with acute coronary syndrome.
New oral anticoagulants under development that target factor IIa and factorXa.Participating proteins are depicted by their zymogen symbols for simplicity.FactorX and its activation toXa,and FactorII and its activation toIIa are more fully illustrated,because these two proteases are targets of the therapeutic agents in the shaded boxes.Bold arrows from the shaded boxes point to the proteases that those agents inhibit,and anagent with aline through it has been withdrawn from development.
Dabigatran's A Direct Thrombin Inhibitor emergence as a second option for oral anticoagulation in AF.With several other oral anticoagulants encroaching on likely FDA review for approval for the AF indication, dabigatran is for the time being the only available warfarin alternative in AF. Many patients and clinicians find warfarin difficult to manage and are welcoming another oral anticoagulation option. Exceptions, according to that latest update, include those with prosthetic heart valves or hemodynamically significant valve disease, severe renal failure, or advanced liver disease.
But the new statement cautions that warfarin may still be appropriate for some patients. "Because of the twice-daily dosing and greater risk of nonhemorrhagic side effects with dabigatran, patients already taking warfarin with excellent [international normalized ratio] INR control may have little to gain by switching to dabigatran," it states.
2011 Medscape
Mitral regurgitation is common, with 80% of us
having some normal valve leakage detectable on
echocardiography. Mild regurgitation is well tolerated and rarely leads to overt clinical disease.
nejm.org april 14, 2011
Mild regurgitation is well tolerated and rarely leads to overt clinical disease.However, severe regurgitation overloads the left ventricle as blood is pumped both backward across the mitral valve and forward to the systemic circulation.Over time, volume overload results in ventricular dilatation and eventual contractile dysfunction.In addition, increased left atrial pressure leads to atrial fibrillation and pulmonary hypertension. If untreated, these physiological changes lead to heart-failure symptoms and reduced survival. Both can be prevented by an intervention to eliminate mitral regurgitation at the onset of symptoms or before any irreversible changes in cardiac function occur.
Currently,our choices for intervention are surgical mitral valve repair or replacement, with repair preferred whenever possible because it has a low operative mortality (about 2%), restores normal valve function, and provides excellent long-term outcomes. In patients with primary leaflet disease and severe regurgitation, adverse outcomes are directly due to the physiological effects of valve dysfunction. Thus, the key element in clinical care is periodic noninvasive
monitoring of valve and ventricular function in
patients at risk for adverse outcomes in order to
ensure optimal surgical timing.
In contrast, adverse outcomes are largely determined by the underlying myocardial disease in patients with functional mitral regurgitation.
Thus, clinical management focuses on treatment
of the causal disease process, rather than on direct attempts to decrease regurgitant severity, particularly if treatment normalizes ventricular size, shape, and systolic function, allowing better
alignment of the mitral-valve apparatus and more complete valve closure.
For example, in patients with dilated cardiomyopathy, regurgitant severity often improves substantially with medical therapy or biventricular pacing. Similarly, in patients with coronary artery disease, regurgitation may improve after revascularization.
A subgroup of patients with persistent severe functional mitral regurgitation may benefit from a reduction in regurgitant severity, although this approach remains controversial.
Feldman and colleagues report the results of
a randomized, prospective trial of a percutaneously inserted mitral valve clip for the treatment of severe regurgitation.The idea that valve regurgitation might be treated
with a nonsurgical approach is exciting, particularly
if the new procedure effectively reduces
regurgitant severity with a low procedural risk.
Ideally, any new procedure would also be at least
equivalent to surgical valve repair in terms of
safety, function, durability, and long-term outcomes.
The mitral-valve clip that was evaluated in this study fulfills some, but not all, of these criteria.As compared with mitral-valve surgery, the mitral clip was associated with a lower rate of complications at 30 days. However, it is disappointing that by 1 year after the procedure, 20% of patients in the percutaneous-treatment group required surgery for mitral-valve dysfunction, as compared with 2% of patients in the surgical group who required repeat surgery.
It is of particular concern that substantial residual regurgitation (grade 2+ or more) was present in 46% of patients in the percutaneous-treatment group, as compared with 17% in the surgical group at 12 months.
This modest reduction in regurgitant severity might be associated with favorable short-term and midterm outcomes, but surgical series suggest that residual mitral regurgitation predicts adverse long-term clinical outcomes.
This issue is further confused by the inclusion
of both patients with primary leaflet disease and those with functional regurgitation; these are different diseases with different clinical outcomes.Despite these concerns, the authors are to be commended for performing a rigorous clinical trial with objective measures of valve and ventricular function, as well as clinical outcomes. Regardless of whether the mitral clip becomespart of our clinical toolkit, we will face some
difficult challenges in clinical decision making as
new minimally invasive devices become clinically
available during the next few years.
Surgical correction of severe valve dysfunction has provided dramatic improvements in clinical outcomes of adults with valvular heart disease during the past several decades. As we embrace new approaches to mechanical correction of abnormal valve hemodynamics, we need to be sure that we do not sacrifice proven long-term effectiveness for short-term issues, such as convenience,
invasiveness, or reversible procedural complications.
The goal is to make the patient
feel better and live longer.
nejm.org april 14, 2011
The overall mortality of symptomatic patients with DHF or SHF is very similar and is related to the functional class. In patients with New York Heart Association Class II and III DHF, an annual mortality rate of 3.8% was observed.
In patients who required hospital admissions for treatment,
1-year all cause death was 27% in DHF
and 36% in SHF
In systolic heart failure approximately 50% of deaths are sudden and the rate of sudden death in systolic heart failure is 6 to 9 times higher compared with that in the general population. Interestingly, with the increased severity of systolic heart failure (New York Heart Association IV), incidence of sudden cardiac death decreases. The absolute rates of pump failure death and sudden cardiac death increases with decreasing left ventricular ejection fraction. However, it has been reported that the risk of sudden cardiac death is better correlated to left ventricular
mass than to the ejection fraction.
Differences in Therapeutic Options
Although there have been considerable advances in the treatment of SHF, very little progress has been made in the management of DHF. The improvement in prognosis in SHF is most likely related to the therapeutic discoveries that have been observed to attenuate adverse remodeling and improve hemodynamic abnormalities.The neurohormonal modulators such as renin-angiotensin-aldosterone and adrenergic antagonists clearly improve symptoms and quality of life and decrease mortality. So far no such therapies have been discovered for improving prognosis in patients with DHF.
Angiotensin receptor blocking agents have the potential for decreasing morbidity but not mortality.
It has been reported that statin therapy has the potential to decrease mortality of patients with DHF.
Statin therapy is also associated with lower mortality in SHF. Chronic resynchronization therapy with or without
implantable cardioverter defibrillator improves prognosis of patients with SHF. However, chronic resynchronization therapy has not been shown to produce beneficial effects in DHF.
Cardiac transplantation is likely to benefit selected
patients either with SHF or DHF.
Established clinical systolic and diastolic heart failure appear to be 2 distinct syndromes of chronic heart failure.The myocardial structural and primary functional derangements are distinctive in these 2 syndromes, although hemodynamic consequences, clinical presentations, signs and symptoms, and prognosis are similar. The neurohormonal abnormalities are also similar in both of these syndromes.
Although there have been considerable advances in themanagement of systolic heart failure, the management of DHF remains primarily to relieve symptoms. Because of inadequate knowledge of the molecular and biochemical mechanisms of the structural remodeling and principal functional derangement in diastolic heart failure, treatments to improve prognosis have not evolved. Thus further basic science and clinical research is urgently required.
Heart failure affects 1% of people aged 50 years, about 5% of those aged 75 years or older, and 25% of those aged 85 years or older.The ejection fraction is a calculation of how much blood is ejected out of the left ventricle (stroke volume), divided by the maximum volume remaining in the left ventricle at the end of diastoleor relaxation phase. A normal ejection fraction is greater than 50%. Systolic heart failure has a decreased ejection fraction of less than 50%. The rate of death from heart failure is about 10% after 1 year. About half of those with CHF die within 5 years after their diagnosis
Drug Therapy - General Principles
With some exceptions, many of the drugs used to treat systolic heart pressure are also used to treat diastolic heart failure. However, the reason they are used and the dose may be different for DHF.For example, in DHF beta-blockers are used to make filling the heart with blood take longer, and to change the heart's response to exercise. In SHF, beta-blockers are used to increase pumping power and reverse heart remodeling. Diuretic dose for DHF is usually much smaller than for SHF. Calcium channel blockers have no place in SHF treatment but may help DHF.• The first step in treating DHF patients is to reduce lung congestion. You do that by lowering pulmonary (lung) pressure. This has 3 steps:
• Reduce heart size
• At first, heart size can be reduced by restricting fluid and sodium intake, by dialysis or filtering the blood, plasmapheresis, and diuretics. Relaxing (dilating) the blood vessels using nitro or morphine is effective but should be started at low doses to avoid low blood pressure. Low blood pressure can be a real problem in DHF patients. Long-term treatment should include small to moderate diuretic doses, mild doses of long-acting nitro, and restricted sodium intake. Aldactone (spironolactone) may be effective long-term because it suppresses the RAS. ACE inhibitors and ARBs reduce fluid retention and oxygen demand.
• Make the heart's chambers beat together as a team
• The second step in lowering pulmonary pressure is to keep the heart's upper chambers (atriums) beating properly. Atrial fibrillation is poorly tolerated in DHF patients because it increases diastolic pressures, causing lung congestion and low blood pressure.In patients with a-fib, restoring normal rhythm should be a priority. Patients who need a pacemaker should have atrial pacing as well as ventricular pacing.
• Slowing the heart rate
• The third step in lowering pulmonary pressures is to slow the heart rate. This gives the heart more time to relax so it can fill with blood. Fast heart rate is poorly tolerated in DHF patients because rapid heart rate:
• increases the heart's oxygen demand and reduces blood flow to the heart, causing ischemia even without CAD
• prevents full relaxation of the heart muscle, which raises pressure and reduces the heart's flexibility
• shortens the heart's relaxation period, making it incomplete, which reduces the amount of blood pumped per beat
For these reasons, most doctors use beta-blockers and calcium channel blockers to slow the heart rate a lot in DHF patients. However, slowing the heart rate too much can reduce cardiac output despite better filling. This is why DHF patients need very individualized treatment. An initial goal might be a resting heart rate of about 60 beats per minute.Beta-blockers and calcium channel blockers increase the time it takes the heart to fill with blood. This helps keep pulmonary pressures low. However, these drugs also directly reduce the heart's ability to relax by their effects at the cell level. It's a tricky balance to strike in DHF patients. The overall effect of these drugs in DHF patients is improved symptoms.
The long-term effect of calcium channel blockers on diastolic heart failure patients is unknown. All calcium channel blockers except amlodipine increase mortality in patients with systolic heart failure.
Nebivolol Helps CHF Seniors with Normal EF
March 27, 2006 - A "third generation" (new) beta-blocker called Nebivolol is on the way. Nebivolol has the main good benefit of Toprol-XL (beta-1 blocking without beta-2 blocking) plus one of the good benefits of Coreg (relaxing the arteries, called vasodilation). It also helps endothelial function and is a powerful anti-oxidant. Nebivolol does this without all of Coreg's side effects.Researchers studied how nebivolol affects systolic versus diastolic left heart function in patients. This substudy included 104 patients; 43 had an EF less than 36%. Echo was done on each patient to take quite a few heart measures at study start and again one year later.In the group with EF less than 36%, nebivolol reduced heart size and improved EF 5%. Other measures remained the same. In patients with EF higher than 36%, no changes in the heart muscle were seen.So in patients with weakly pumping hearts (low EF), nebivolol reduces heart size and improves EF.
In patients with near-normal or normal EF (diastolic heart failure) no changes in the heart muscle were seen. None the less, risk of death or heart-related hospitalization improved in both groups in SENIORS.
The SENIORS trial showed that nebivolol reduces risk of death and heart-related hospitalizations in senior CHFers regardless of EF. What does this mean? It suggests that CHFers with diastolic heart failure may now have a drug proven to help them.
Inotropes
Since ejection fraction is often okay in DHF patients, inotropes may give no benefit at all. However, such drugs can cause harm in these patients. Inotropic drugs may help in the short-term for lung congestion but even short-term use may cause ischemia, speed up heart rate, or trigger arrhythmias.Digoxin (Lanoxin, digitalis)
Digoxin (Lanoxin) strengthens the heart's pumping power. This increases energy demand, which may only show up during stress like exercise or ischemia, when digoxin can worsen diastolic function. With the exception of patients in chronic atrial fibrillation (to slow ventricular rate), digoxin is not recommended for DHF
• Questions and Answers
• Question• Is the rise in DHF cases caused by doctors better recognizing the condition or has there been an actual increase in the number of cases?
• Dr. Zile
• I think it is both. We are recognizing it better. Also, the general population is aging so high blood pressure, heart disease, and diabetes are rising just because they are more common in the elderly. Age itself causes changes in the heart that encourage DHF
Question
Why the controversy surrounding the diagnosis of DHF?Dr. Zile
The guidelines that exist or have been proposed come from the European Cardiology Society and the Canadian Heart Society, They all require that 3 standards be met to diagnose DHF:1) signs and symptoms of heart failure2) normal EF3) problems with diastolic function seen by cath or echoI think these criteria are too tight and that number 3 should be eliminated. Ninety percent of patients who fit the first 2 will indeed turn out to have diastolic heart failure confirmed by cath. The problem arises because measuring diastolic function with noninvasive tests like echo is difficult and confusing.Why? Echo usually measures what we call the E and A velocities. However, E-wave velocity drops with age, heart enlargement, and DHF. So in someone with congested lungs and signs of high heart pressures those E-waves can appear normal. While the E-wave should be low in DHF patients, it may appear normal if the doctor is not experienced at treating diastolic heart failure.
• Question
• Is finding diastolic problems on an echo that is done for another reason important, even in a patient with no history or symptoms of CHF?
• Dr. Zile
• Yes. In systolic heart failure, a wide range of patient types is seen - from those with low EFs but no symptoms, to those with mild or moderate symptoms, to class 4 patients with severe symptoms even at rest. The same range is likely to be seen in diastolic heart failure patients
• Question
• Since most of the blood that fills the LV does so in the early part of the filling phase, why does it help to lengthen that phase in DHF patients by slowing heart rate? Doesn't increasing heart rate increase cardiac output?
• Dr. Zile
• While speeding up heart rate increases output, it also raises pressure, making symptoms worse. In a healthy person, raising heart rate does not change pressures much because the ventricle is able to relax faster as heart rate speeds up.However, in DHF patients, the response to increased heart rate is not normal. When heart rate speeds up, the ventricle cannot relax any faster. This raises pressures. By slowing heart rate, you give the ventricle more time to relax, lowering filling pressures. Also, many DHF patients have ischemia. By slowing the heart rate, you reduce the heart's need for oxygen and that helps balance supply and demand of blood and oxygen
• Question
• Seeing that pretty much the same drugs are used to treat both diastolic are systolic heart failure, how important is it to tell DHF from SHF?• Dr. Zile
• There are at least 40 well-done trials to guide treatment for systolic heart failure patients. This is not true for DHF, so its treatment is less certain. Even though we say ACE inhibitors will probably help and ARBs may help, and beta-blockers may help, and so on, it is not proven in large numbers of DHF patients. Also, there are differences in the way you use those drugs and in the doses you use.The best example is beta-blockers. Treating heart failure in patients with an EF of 30% requires that beta-blocker dose be raised carefully, starting with tiny doses and raising it slowly over several months. In the DHF patient, that very slow rise in dose is not usually necessary.Another example is calcium channel blockers. These drugs should not be used in systolic heart failure patients at all, but they may help DHF patients. As another example, diuretic use needs to be much more cautious in the DHF patient since drying them out too much can easily cause too-low blood pressure.So even though the same drugs may be used to treat SHF and DHF, there are important differences. It is important for doctors to be aware of the differences when treating CHF patients
• Question
• Have beta-blockers and calcium channel blockers been shown to reverse measurements of diastolic dysfunction?• Dr. Zile
• If you give beta-blockers to DHF patients, their relaxation rate gets worse instead of better. Despite this, patients feel better - so measurements don't always agree with how patients actually do while taking a drug. With calcium channel blockers, DHF patients feel better while taking them and their filling rates usually get better. There is a complex relationship between how any one drug affects a person versus how that drug affects the measurements we take of that person's heart function.One study that used a calcium channel blocker and another study using an ARB showed improved exercise times in patients taking these drugs. However, neither study showed improved measurements of heart relaxation or stiffness. I don't think you can rely just on measures of heart function to guide treatment.
• Question
• In making a DHF diagnosis, what must be ruled out besides systolic heart failure?• Dr. Zile
• Besides excluding SHF, it is also important to rule out mitral valve stenosis and chronic lung disease, both of which can imitate heart failure with a normal EF
• Question
• What blood pressure drugs are most likely to help heart enlargement in DHF patients?
• Dr. Zile
• Although it hasn't been clearly proven yet, I think drugs that alter the neurohormonal systems work well. They not only lower pressure, but they also reduce the effects of overactive bodily systems. The problem is that in most trials, heart enlargement only goes down about 10 to 15%. This will probably improve heart function but not totally reverse DHF. If those high blood pressure trials had been longer by 5 or 10 years, we might have seen more improvement proven down the road.What evidence do I have to support that? The answer comes from patients with aortic stenosis who had their aortic valves replaced. Three to 5 years after aortic valve replacement, ventricular size and stiffness often returned to normal, improving the heart's stiffness and relaxation
Is narrowing of the aortic valve obstructing blood flow from the left ventricle to the ascending aorta during systole. Causes include
a congenital bicuspid valve,
idiopathic degenerative sclerosis with calcification, and
rheumatic fever.
Aortic stenosis
Progressive untreated AS ultimately results in one or more of the classic triad of
syncope, angina, and exertional dyspnea; heart failure and arrhythmias may develop. A carotid pulse with small amplitude and delayed upstroke and a crescendo-decrescendo ejection murmur are characteristic. Diagnosis is by physical examination and echocardiography. Asymptomatic AS often requires no treatment. For progressive severe or symptomatic AS in children, balloon valvotomy is used; adults require valve replacement.Aortic sclerosis, a degenerative aortic valve disease with thickening of aortic valve structures by fibrosis and calcification initially without causing significant obstruction, is the most common cause of AS in elderly patients. Over years, aortic sclerosis progresses to stenosis in as many as 15% of patients.
Aortic sclerosis resembles atherosclerosis, with deposition of lipoproteins, active inflammation, and calcification of the valves; risk factors are similar.
The most common cause of AS in patients < 70 yr is a congenital bicuspid aortic valve. Congenital AS occurs in 3 to 5/1000 live births and affects more males.
In developing countries, rheumatic fever is the most common cause in all age groups.
Supravalvular AS caused by a discrete, congenital membrane or hypoplastic constriction just above the sinuses of Valsalva is uncommon. A sporadic form of supravalvular AS is associated with a characteristic facies (high and broad forehead, hypertelorism, strabismus, upturned nose, long philtrum, wide mouth, dental abnormalities, puffy cheeks, micrognathia, low-set ears). When associated with idiopathic hypercalcemia of infancy, this form is known as Williams syndrome. Subvalvular AS caused by a congenital membrane or fibrous ring just beneath the aortic valve is uncommon
Pathophysiology
Aortic regurgitation may accompany AS, and about 60% of patients > 60 yr with significant AS also have mitral annular calcification, which may lead to significant mitral regurgitation.The left ventricle (LV) gradually hypertrophies in response to AS. Significant LV hypertrophy causes diastolic dysfunction and, with progression, may lead to decreased contractility, ischemia, or fibrosis, any of which may cause systolic dysfunction and heart failure (HF). LV chamber enlargement is a late finding unless there is coexisting MI.
Patients with AS have a higher incidence of GI bleeding (Heyde's syndrome) because the high shear stress of stenotic valves makes multimeric von Willebrand's factor more susceptible to cleavage by a plasma metalloprotease and may increase platelet clearance.
GI bleeding may also be due to angiodysplasia.
Symptoms and Signs
Congenital AS is usually asymptomatic until at least age 10 or 20 yr, when symptoms may begin to develop insidiously. In all forms, progressive untreated AS ultimately results in exertional syncope, angina, and dyspnea (SAD triad). Other symptoms and signs may include those of HF and arrhythmias, including ventricular fibrillation leading to sudden death.
Exertional syncope occurs because cardiac output cannot increase enough to meet the demands of physical activity. Nonexertional syncope may result from altered baroreceptor responses or ventricular tachycardia.
Exertional angina pectoris affects about 2/3 of patients; about ½ have significant coronary artery atherosclerosis, and ½ have normal coronary arteries but have ischemia induced by LV hypertrophy, altered coronary flow dynamics, or both.
There are no visible signs of AS. Palpable signs include carotid and peripheral pulses that are reduced in amplitude and slow rising (pulsus parvus, mollus et tardus) and an apical impulse that is sustained (thrusts with the 1st heart sound [S1] and relaxes with the 2nd heart sound [S2]) because of LV hypertrophy. The LV impulse may become displaced when systolic dysfunction develops. A palpable 4th heart sound (S4), felt best at the apex, and a systolic thrill, corresponding with the murmur of AS and felt best at the left upper sternal border, are occasionally present in severe cases. Systolic BP may be high with mild or moderate AS and falls as AS becomes more severe.
On auscultation, S1 is normal and S2 is single because aortic valve closing is delayed and merges with the pulmonic (P2) component of S2. The aortic component may also be soft. Paradoxical splitting of S2 may be heard. An S4 may be audible. An ejection click may also be audible early after S1 in patients with congenital bicuspid AS when valve leaflets are stiff but not completely immobile. The click does not change with dynamic maneuvers.
The hallmark finding is a crescendo-decrescendo ejection murmur, heard best with the diaphragm of the stethoscope at the right and left upper sternal border when a patient who is sitting upright leans forward. The murmur typically radiates to the right clavicle and both carotid arteries (left often louder than right) and has a harsh or grating quality. But in elderly patients, vibration of the unfused cusps of calcified aortic valve leaflets may transmit a louder, more high-pitched, “cooing” or musical sound to the cardiac apex, with softening or absence of the murmur parasternally (Gallavardin's phenomenon), thereby mimicking mitral regurgitation
The murmur is soft when stenosis is less severe, grows louder as stenosis progresses, and becomes longer and peaks in volume later in systole (ie, crescendo phase becomes longer and decrescendo phase becomes shorter) as stenosis becomes more severe. As LV contractility decreases in critical AS, the murmur becomes softer and shorter. The intensity of the murmur may therefore be misleading in these circumstances.
The murmur of AS typically
increases with maneuvers that increase LV volume and contractility (eg, leg-raising, squatting, Valsalva release, after a ventricular premature beat) anddecreases with
maneuvers that decrease LV volume (Valsalva maneuver) or increase afterload (isometric handgrip).
These dynamic maneuvers have the opposite effect on the murmur of hypertrophic cardiomyopathy, which can otherwise resemble that of AS.
The murmur of mitral regurgitation due to prolapse of the posterior leaflet may also mimic AS.
Diagnosis
Echocardiography
Diagnosis is suspected clinically and confirmed by echocardiography. Two-dimensional transthoracic echocardiography is used to identify a stenotic aortic valve and possible causes, to quantify LV hypertrophy and degree of diastolic or systolic dysfunction, and to detect coexisting valvular heart disorders (aortic regurgitation, mitral valve disorders) and complications (eg, endocarditis).
Doppler echocardiography is used to quantify degree of stenosis by measuring aortic valve area, jet velocity, and transvalvular systolic pressure gradient.
A valve area of 0.5 to 1.0 cm2 or a mean gradient > 45 to 50 mm Hg represents severe stenosis. The gradient may be overestimated in aortic regurgitation and underestimated in LV systolic dysfunction. The rate of progression of AS from mild to severe is quite variable and does not necessarily proceed in a linear fashion.
Cardiac catheterization is necessary to determine whether coronary artery disease (CAD) is the cause of angina and, occasionally, to resolve differences between clinical and echocardiographic findings.
An ECG and chest x-ray are obtained. ECG typically shows changes of LV hypertrophy with or without an ischemic ST- and T-wave pattern.
Chest x-ray findings may include calcification of the aortic cusps (seen on the lateral projection or on fluoroscopy) and evidence of HF.
Heart size may be normal or only mildly enlarged.
Prognosis
AS may progress slowly or quickly and thus requires regular follow-up to detect progression, particularly in sedentary elderly patients. In such patients, flow may become significantly compromised without triggering symptoms.Overall, about 3 to 6% of asymptomatic patients with normal systolic function develop symptoms or LV ejection fraction depression every year.
However, surgery is usually delayed until symptoms develop because the risk of surgery outweighs the survival benefit in asymptomatic patients. Surgery should not be delayed once symptoms develop.
Mean survival in untreated symptomatic patients is about 2 to 3 yr.
Aortic valve replacement relieves symptoms and improves survival. Risk with surgery increases for patients who require simultaneous coronary artery bypass graft (CABG) and for those with depressed systolic LV function.About 50% of deaths occur suddenly. While awaiting surgery, patients with severe AS should be advised to restrict physical exertion.
Treatment
Asymptomatic patients with a maximum gradient ≤ 25 mm Hg and a valve area > 1.0 cm2 have a low mortality and low overall risk of requiring surgery in the next 2 yr; annual evaluation for symptom progression, including echocardiography to determine gradient and valve area, is appropriate.
Asymptomatic patients with gradients of 25 to 50 mm Hg or valve area < 1.0 cm2 are at higher risk of developing symptoms in the next 2 yr, but generally elective valve replacement is not required in the absence of symptoms.
Valve replacement is indicated for patients who have moderate or severe AS and primarily require CABG. Surgery may be indicated for patients who become hypotensive during exercise treadmill testing and for those with LV ejection fraction < 50%.
Patients with ventricular arrhythmias and severe LV hypertrophy are also often referred for surgery, but benefits are less clear, patients without any of these qualifying conditions include more frequent monitoring for progression of symptoms, LV hypertrophy, gradients, and valve area with medical management as needed.
It is unclear whether statins reduce the progression of AS. Other drugs may be detrimental, especially those that can cause hypotension. Small studies suggest that perhexilene maleate may decrease symptoms.
Nitroprusside Some has been used as a temporizing measure to reduce afterload in patients with decompensated HF in the hours before valve replacement, but because this drug can have the same effect as rapid-acting nitrates, it must be used cautiously and monitoring is required.
Symptomatic patients should undergo valve replacement or balloon valvotomy.
Valve replacement is indicated for virtually all who can tolerate surgery.
In younger patients, the patient's own pulmonic valve can be used, providing good durability;a bioprosthesis is then used to replace the pulmonic valve (Ross procedure).
Most often, the aortic valve is replaced with a mechanical or bioprosthetic valve. Preoperative evaluation for CAD is indicated so that CABG and valve replacement, if indicated, can be done during the same procedure.
Balloon valvotomy is used primarily in children and very young adults with congenital AS.
In older patients who are unfit for surgery, balloon valvuloplasty can provide temporary relief of symptoms, perhaps for 6 to 12 mo, and can be repeated in selected patients.
Minimally invasive valve replacement is being investigated as an alternative procedure.
Duration of anticoagulation for venous thromboembolism
BMJ 30 March 2011
Three months of treatment achieves a similar
risk of recurrent venous thromboembolism after stopping anticoagulation to a longer course of treatment.Unprovoked proximal deep vein thrombosis and
pulmonary embolism have a high risk of recurrence whenever treatment is stopped.
The decision to continue anticoagulant
treatment beyond the first few months is based on the treating physician’s perception of the benefits and harms of continuing treatment and on the patient’s preference.The benefits and harms associated with different
lengths of vitamin K antagonist treatment have
been evaluated in several studies that randomly allocated patients with venous thromboembolism to
receive different lengths of treatment.
Three clear messages have emerged from the findings of these studies.
Firstly, in unselected patients with venous thromboembolism, shortening the length of treatment from three or six months to 1.0 or 1.5 months results in asubstantial increase in the frequency of recurrent thromboembolism after anticoagulants are stopped Secondly, vitamin K antagonist treatment targeted to an international normalised ratio of 2.5 is very effective at preventing recurrent venous thromboembolism.Thirdly, the risk of recurrent thromboembolism
increases after vitamin K antagonist treatment is
stopped.
However, the results of these individual
trials, and meta-analysis of summary data of their
findings, have failed to answer many important questions relating to the optimal length of vitamin K antagonist treatment for venous thromboembolism.
BMJ 30 March 2011
Venous thromboembolism affects
2-3 per 1000 men and women annually, with a case fatality rate of around 10%, and it results inpost-thrombotic syndrome in about a quarter of patients. After anticoagulant treatment is stopped, venous thromboembolism often recurs, with reported cumulative incidences ranging from
19% to 30% in cohorts followed for two to eight years. Vitamin K antagonists reduce the risk of recurrent thromboembolism by more than 80%
BMJ 2011;342:
Boutitie and colleagues compare outcomes after different lengths of anticoagulant treatment.there is no benefit of continuing to treat for more than three months if the intention is to stop eventually, regardless of the initial location of venous thromboembolism and the presence of provoking risk factors.
However, an anticoagulant course shorter than three months increases the risk of recurrent venous thromboembolism by 50%
The guidelines of the American College of Chest Physicians (ACCP), which were written by a subset of the authors of the meta-analysis, recommend at least a three month course for all patients with an unprovoked episode of venous thromboembolism, and indefinite anticoagulant treatment for patients with a first unprovoked proximal deep vein thrombosis or pulmonary embolism and a low risk of bleeding when this concurs with the patient’s preference. This recommendation is based on the absolute risk of recurrence of about 10 per 100 patient years that is seen in these patients.
The problem is the associated risk of bleeding. A meta-analysis of 33 trials and prospective cohort studies showed that the case fatality rate of major bleeding was 13.4% (9.4% to 17.4%) and the rate of intracranial bleeding was 1.15 (1.14 to 16) per 100 patient years. For patients who received anticoagulants for more than three months—that is, those patients who might be considered for lifelong treatment according to the ACCP guidelines—the case fatality rate of major bleeding remained high at 9.1% (2.5% to 21.7%), and the rate of intracranial bleeding was 0.65 (0.63 to 0.68) per 100 patient years.
Given that the case fatality rate of recurrent venous thromboembolism decreases over time, whereas the risk of major bleeding increases with age, the optimum length of anticoagulant treatment after an episode of venous thromboembolism remains uncertain. In accordance with this, many clinicians are not ready to prescribe indefinite treatment in all patients with an unprovoked proximal deep vein thrombosis or pulmonary embolism.
Unfortunately, the current patient level meta-analysis has been unable to answer important questions in the search for better risk stratification of patients by simple prognostic characteristics including sex, presence of intermediate risk factors such as oestrogen use, and indicators of an ongoing prothrombotic state. Such analyses are urgently needed to determine which patients with unprovoked venous thromboembolism have a high enough risk of recurrence to justify the use of harmful drugs indefinitely.
BMJ 2011;342:
If the risk of recurrent venous thromboembolism is not high enough to justify indefinite anticoagulation, treatment can be stopped after three months in most patients
The risk of recurrence after stopping anticoagulants is doubled if venous thromboembolism was a proximal deep vein thrombosis or pulmonary embolism compared with an isolated distal deep vein thrombosis
The risk is also doubled if thrombosis was unprovoked rather than provoked by a temporary risk factor, and the influence of these two factors on the risk of recurrence is additive
BMJ 2011;342
New Direct Thrombin Inhibitor
Dabigatran is an oral direct thrombin inhibitor that wasapproved by (FDA)
for the prevention of stroke and systemic embolism in
patients with atrial fibrillation in October 2010. Approval by FDA was based largely on the results of the
RE-LY study, a phase III, randomized, partial double-blind,non-inferiority study comparing two dosages of the drug (110 mg and 150 mg twice daily) with adjusted-dose warfarin (target international normalized ratio [INR] 2-3)
In more than 18,000 patients with non-valvular atrial fibrillation who were at high risk for stroke. Dabigatran is eliminated primarily by the kidneys, so patients with severe renal insufficiency and a creatinine clearance less than 30 mL/min were excluded from the study.
The primary efficacy outcome was stroke or systemic embolism,and the primary safety outcome was major bleeding.After a median follow-up time of 2 years, the larger of the two dabigatran dosages (150 mg twice daily) was superior in efficacy and non-inferior in safety to warfarin.
The risk for stroke or systemic embolism was 34% lower with dabigatran 150 mg twice daily than warfarin. The smaller of the two dabigatran dosages (110 mg twice daily) was non-inferior in efficacy and superior in safety to warfarin.
The rate of intracranial hemorrhage, the most devastating complication of warfarin therapy and a secondary endpoint in the RE-LY study, was significantly lower with both dabigatran dosages than warfarin.
The rate of gastrointestinal major bleeding was significantly higher with the larger dabigatran dosage than warfarin,although there was no significant difference between the lower dabigatran dosage and warfarin in rate of this
end point.
The incidence of dyspepsia was significantly
higher with both dabigatran dosages than warfarin,although the incidence of other adverse effects was similar with both dabigatran dosages and warfarin.
According to ACC,AHA, and HRS, dabigatran is useful as an alternative to warfarin for the prevention of stroke and systemic thromboembolism in patients with paroxysmal to permanent atrial fibrillation and risk factors for stroke or systemic embolization
who do not have a prosthetic heart valve or hemodynamically significant valve disease,
severe renal failure (creatinine clearance <15 mL/min)
or advanced liver disease (impaired baseline clotting function).
The tradeoff between efficacy and safety posed aconundrum for FDA in determining which of the two dosages to approve. The agency approved the larger 150 mg twice daily dosage for patients with a creatinine clearance exceeding 30 mL/min and 75 mg twice daily for patients with severe renal insufficiency (a creatinine clearance of 15-30 mL/min), although the 75 mg twice daily dosage is based on pharmacokinetic modeling, not clinical data.
Rivaroxaban
Is an oral direct factor Xa inhibitor under investigation for prevention of stroke and systemic embolism in patients with atrial fibrillation and prevention of venous thromboembolism (VTE) in patients undergoing major orthopedic surgery. The drug was approved for VTE prevention in Europe in 2008. An FDA advisory committee recommended approval of rivaroxaban for VTE prevention in March 2009, but additional data were requested by the agency in May 2009.4 These data recently were resubmitted to FDA. Approval of the drug by FDA is feasible in 2011.40-month, randomized,double-blind, double-dummy, non-inferiority study, rivaroxaban 20 mg/day (15 mg/day for patients with renal impairment) was compared with adjusteddose warfarin (INR 2-3) in more than 14,000 patients with non-valvular atrial fibrillation who were at high risk for stroke. In the on-treatment analysis, rivaroxaban was judged superior to warfarin in efficacy, with a 21% lower risk for stroke and systemic embolism (the primary efficacy endpoint) compared with warfarin.
In the intention-to-treat analysis, a more conservative analysis that includes patients who dropped out of the study and may better represent use of the drug outside a clinical trial setting, rivaroxaban was non-inferior to warfarin in efficacy. There was no significant difference between rivaroxaban and warfarin in major bleeding and nonmajor clinically-relevant bleeding, the primary safety endpoint. However, the incidence of intracranial hemorrhage was significantly lower in rivaroxaban-treated patients(0.49%) than in warfarin-treated patients (0.74%). These findings suggest that rivaroxaban may be a safe and effective alternative to warfarin for patients with atrial fibrillation who are at high risk for stroke.
Apixaban
Apixaban is an oral direct factor Xa inhibitor that is under investigation for stroke prevention in patients with atrial fibrillation and for VTE prevention. An application for approval of the VTE prevention indication was submitted to European regulatory authorities in June 2010. The Apixaban Versus Acetylsalicylic Acid to Prevent Strokes study (known as AVERROES) was a double-blind, double-dummy, superiority trial in 5599 patients with atrial fibrillation and at least one risk factor for stroke who were not candidates for warfarin therapy.Apixaban 5 mg twice daily (2.5 mg twice daily for patients with advanced age, impaired renal function, or low body weight) was compared with aspirin 81-324 mg once daily for up to 36 months. The study was stopped early because the rate of stroke and systemic embolism was significantly lower with apixaban (1.6% per year) than with aspirin (3.7% per year). There was no significant difference between the treatments in bleeding (1.4% per year and 1.2% per year, respectively). The results were presented at the European Society of Cardiology Congress in August 2010
The Apixaban for the Prevention of Stroke in Subjects With Atrial Fibrillation (ARISTOTLE) study is in progress to provide insight into how apixaban compares with warfarin for preventing stroke and systemic embolismand its impact on the risk for bleeding. In this phase III, randomized, double-blind, double-dummy, noninferiority study, more than 18,000 patients with persistent or permanent atrial fibrillation and at least one risk factor for stroke will receive apixaban 5 mg twice daily (or 2.5 mg twice daily for patients with advanced age,renal impairment, or a low body weight) or adjusteddose warfarin (INR 2-3) for at least 12 months and up to 4 years.
Stroke and systemic embolism is the primary efficacy outcome, and major bleeding (excluding clinically-relevant non-major bleeding) is the primary
safety outcome. The results of the ARISTOTLE study are expected this spring. Approval of the drug by FDA could occur in 2011.
Sites of action of the new oral anticoagulants. By targeting thrombin, thrombin inhibitors (such as dabigatran) block thrombin mediated conversion of fibrinogen to fibrin, which leads to clot formation, as well as thrombin mediated feedback activation of coagulation factors V and VIII. Factor Xa inhibitors (such as rivaroxaban and apixaban) block the conversion of prothrombin to thrombin by the prothrombinase complex (the complex of factor Xa and factor Va bound to the surface of the activated platelet). Heparin targets thrombin and factor Xa equally well, whereas low molecular weight heparin targets factor Xa to a greater extent than thrombin, and fondaparinux targets only factor Xa. Vitamin K antagonists, such as warfarin, reduce the levels of factors II, VII, IX, and X as well as protein C and S
Cumulative exposure to bacteremia from daily oral activities (e.g., chewing, brushing, flossing) is thousands of times greater than exposure from a few dental visits yearly.
Antibiotics not advised before dental work
• In a marked departure from prior guidelines, new recommendations released by the American Heart Association emphasize that most patients undergoing dental procedures do not need antibiotics to prevent infective endocarditis, The new recommendations• an artificial heart valve
• prior infective endocarditis
• certain congenital heart defects
• a cardiac transplant complicated by heart valve dysfunction
• 1. Prophylaxis is now recommended only for patients with these four conditions:
• prosthetic cardiac valve• previous infective endocarditis
• certain types of congenital heart disease
• cardiac transplantation with valvulopathy
• 2. For patients with the conditions listed above, prophylaxis should be given only before:
• dental procedures that involve manipulation of gingival tissue or the periapical region of teeth, or perforation of oral mucosa .incision or biopsy of respiratory tract mucosa,procedures on infected skin or musculoskeletal structures
In view of the limited evidence, the AHA has published a new guideline to prevent infective endocarditis
3. Prophylaxis is no longer recommended for gastrointestinal or genitourinary procedures. However, if urine is colonized by enterococcus, eradication before invasive urinary procedures is reasonable.
4. A single 2-g dose of amoxicillin, given 30 to 60 minutes before the procedure, remains the regimen of choice .
The major changes in the updated recommendations include the following:
(1) The Committee concluded that only an extremely small number of cases of infective endocarditis might be prevented by antibiotic prophylaxis for dental procedures even if such prophylactic therapy were 100% effective(2) Infective endocarditis prophylaxis for dental procedures should be recommended only for patients with underlying cardiac conditions associated with the highest risk of adverse outcome from infective endocarditis.
Conclusions
(3) For patients with these underlying cardiac conditions, prophylaxis is recommended for all dental procedures that involve manipulation of gingival tissue or the periapical region of teeth or perforation of the oral mucosa.
(4) Prophylaxis is not recommended based solely on an increased lifetime risk of acquisition of infective endocarditis.
(5) Administration of antibiotics solely to prevent endocarditis is not recommended for patients who undergo a genitourinary or gastrointestinal tract procedure.
Recommendation
conditions as being at increased risk of developing infective endocarditis:• Acquired valvular heart disease with stenosis or regurgitation
• valve replacement
• structural congenital heart disease, including surgically corrected or palliated structural conditions, but excluding isolated atrial septal defect,fully repaired ventricular septal defect or fully repaired patent ductus and closure devices that are judged to be endothelialised
• previous infective endocarditis
• hypertrophic cardiomyopathy.
Recommendation
Antibiotic prophylaxis against infective endocarditis is not recommended:• for people undergoing dental procedures
• for people undergoing non-dental procedures at the following sites :
• upper and lower gastrointestinal tract
• genitourinary tract; this includes urological, gynaecological and obstetric procedures, and childbirth
• upper and lower respiratory tract; this includes ear, nose and throat procedures and bronchoscopy
Recommendation
Chlorhexidine mouthwash should not be offered as prophylaxis against infective endocarditis to people at risk of infective endocarditis undergoing dental procedures.
Recommendation
If a person at risk of infective endocarditis is receiving antimicrobial therapy because they are undergoing a gastrointestinal or genitourinary procedure at a site where there is a suspected infection, the person should receive an antibiotic that covers organisms that cause infective endocarditis.Evidence statement
There is insufficient evidence to determine whether or not antibiotic prophylaxis in those at risk of developing infective endocarditis reduces the incidence of IE when given before a defined interventional procedure(both dental and non-dental)
Chronic rhinosinusitis (CRS) with nasal polyposis is common.
To evaluate the efficacy and safety of a 2-week regimen of oral steroid therapy followed by 26 weeks of sequential topical steroid maintenance therapy. Patients were randomly assigned in a 1:1 ratio to receive oral prednisolone, 25 mg/d, or placebo for 2 weeks, followed in both groups by fluticasone propionate nasal drops, 400 µg twice daily, for 8 weeks and then fluticasone propionate nasal spray, 200 µg twice daily, for 18 weeks.• Ann Intern Med March 1, 2011
Measurements: Polyp grading (primary outcome), hyposmia score, quality of life, symptoms, nasal patency, adrenal function, and bone turnover.
Results: The mean decrease in polyp grade from baseline to 2 weeks was 2.1 units (SD, 1.1) in the prednisolone group and 0.1 unit (SD, 1.0) in the placebo group (mean difference between groups, −1.8 units [95% CI, −2.4 to −1.2 units]; P < 0.001). The difference between groups was −1.08 units (CI, −1.74 to −0.42 unit; P = 0.001) at 10 weeks and −0.8 unit (CI, −1.8 to 0.2 unit; P = 0.11) at 28 weeks. The mean decrease in hyposmia score from baseline to 2 weeks was 31.12 mm (SD, 30.1) in the prednisolone group and 1.41 mm (SD, 30.6) in the placebo group (mean difference between groups, −28.33 mm [CI, −42.71 to −13.96 mm];P = 0.002). The difference between groups was −16.06 mm (CI, −30.99 to −1.13 mm; P = 0.03) at 10 weeks and −12.13 mm (CI, −30.55 to 6.29 mm; P = 0.19) at 28 weeks. Prednisolone therapy resulted in transient suppression of adrenal function and increase in bone turnover after 2 weeks, with a return to baseline at 10 and 28 weeks.
Conclusion: Initial oral steroid therapy followed by topical steroid therapy seems to be more effective over 6 months than topical steroid therapy alone in decreasing polyp size and improving olfaction in patients referred for specialty care of CRS with at least moderate nasal polyposis.
Patients with Gilbert’s syndrome
defect in the gene that encodes for glucuronyltransferase,which results in a 60-70% reduction in the liver’s ability to conjugate bilirubin. This subsequent increase in serum
concentrations of unconjugated bilirubin can lead to intermittent episodes of non-pruritic jaundice, which can be precipitated by fasting, infections, dehydration, surgery, physical exertion, and lack of sleep.
Symptoms, including tiredness, that occur during episodes of jaundice are caused by the precipitating factor and
do not result directly from Gilbert’s syndrome.
BMJ 2011;342:
Drugs that inhibit glucuronyltransferase activity such as
gemfibrozil, and the protease inhibitors atazanavir and indinavir,
can also trigger episodes of jaundice.
Unconjugated hyperbilirubinaemia (conjugated bilirubin is within the normal range and/or <20% of total bilirubin--this is an important distinction because sometimes conjugated bilirubin will be slightly raised but
in those circumstances it should be <20% of the total bilirubin
In cases where diagnostic doubt remains or patients are particularly anxious, genetic testing can be done for confirmation, but this should rarely be necessary.
Over-investigation is the greatest danger to patients with this benign condition. Liver or biliary imaging and referral to secondary care are not needed.
Patient advice and education
• Explain to him that the disorder has occurred as a result of a genetic variation in the way he metabolises the pigment bilirubin, which results in him having slightly higher circulating levels than the average person.• Reassure him that he does not have a disease and that episodes of jaundice are not contagious and will resolve spontaneously within a few days.
• Jaundice does not indicate or result in liver damage, and the condition does not reduce life expectancy or affect life insurance.
• Dietary restrictions are not necessary and alcohol is safewithin recommended limits
• Recommend that he informs medical staff of his disorder if admitted to hospital and when prescribed new medication.
• Tell him to consult you if he has an episode of jaundice that is more severe or persistent than usual because this may indicate a separate condition.
Investigation of an incidental finding of eosinophilia
Eosinophilia is a common abnormality present in 1-1.5% of blood counts in the United Kingdom.The causes of eosinophilia can be grouped into three categories:
• reactive (non-clonal or secondary) disorders;
• clonal (primary) disorders of the bone marrow; and
• Hypereosinophilic yndrome.
BMJ 2011;342:
Reactive (non-clonal or secondary)
infection (especially parasitic—schistosomiasis, hookworm,giardia, filaria, strongyloides),
drugs (such as sulfonamides,penicillins, carbamazepine), allergy, and hypersensitivity
disorders (such as asthma, acute urticaria, and atopic dermatitis); these account for >95% of cases.
Less common
Churg-Strauss syndrome, connective
tissue and autoimmune diseases, and
other infections (such as bacterial, fungal).
Clonal (primary) disorders of the bone marrow
disorders are rare and includechronic myeloid leukaemia
chronic eosinophilic leukaemia.
Hodgkin lymphoma and T cell lymphoma. Hypereosinophilic syndrome
This is extremely rare,accounting for <1% of cases of eosinophilia.
The underlying cause may be evident from the:
• Clinical history (such as atopy, medication history)• Extent of the eosinophilia (for example, when it is caused by atopy, the eosinophil count is rarely >2×109/L, whereas
an eosinophilia of >10×109/L is rare in reactive conditions
Reactive eosinophilias may be transient and resolve within 24 hours of appropriate treatment, as in acute asthma
Eosinophil morphology: in a reactive eosinophilia the morphology is generally normal (figure) and may be accompanied by a neutrophilia. In the rare primary or clonal disorders, the eosinophils may have morphological abnormalities (such as variation in cell size and distribution and number of cytoplasmic granules).
There may be accompanying red cell abnormalities (such as macrocytosis), circulating myeloid precursors, blast cells, or thrombocytosis.
Learning points
When eosinophilia is found, ensure that a blood film has been reviewed. This can give insight into the underlying aetiology If the eosinophil morphology is normal or the blood film appearances favour a reactive (secondary) cause the patient should be reviewed to establish the likely aetiology .Persistence of eosinophilia >1.5×109/L for three months or a rising eosinophil count without an obvious cause warrants referral to a haematologistIntraoperative fluid management guided by
oesophageal Doppler monitoringEffective intraoperative fluid therapy is an essential component of enhanced recovery programmes for patients having major surgery. Conventional haemodynamic monitoring of pulse and blood pressure fails to detect occult hypovolaemia, which occurs in many surgical patients and contributes to inadequate tissue perfusion, leading to organ dysfunction and postoperative complications.
BMJ 2011;342:
On the other hand, large volumes of intravenous
fluid may cause complications due to unwelcome tissue oedema.After major surgery many patients experience complications,which are associated with prolonged hospital stay and adverse long term outcomes. The oesophageal Doppler monitor (Deltex Medical, Chichester, UK) measures stroke volume, allowing the anaesthetist to target intravenous fluid replacement to an individual’s needs, reducing the risk of giving too much or too little fluid.
Evidence from seven randomised controlled trials,
a meta-analysis, and a health technology assessment and procurement review shows that such individualised “goal-directed” fluid therapy with oesophageal Doppler monitoring reduces complications and length of stay after major surgery.BMJ 2011;342:
Patients with platelet abnormalities will usually present with mucous membranes bleeding, also known as microhemorrhages, and increased Bleeding Time (Normal: 1-9 minutes). Patients with coagulation factor abnormalities will present with hemarthroses or bleeding into joints, and increased Partial Thromboplastin Time (PTT) and/or increased Prothrombin Time (PT). PTT is a measurement of the intrinsic coagulation pathway and therefore represents the function of all the coagulation factors except factor VII which is exclusive for the extrinsic pathway which is measure by PT.
Summary points
Patients still die from paracetamol poisoning because they are not recognised to be at risk of harm or present too late for effective treatment
Patients who are malnourished, have been fasting, take enzyme inducing drugs, or regularly drink alcohol to excess are at higher risk of liver damage
Management of paracetamol poisoning
BMJ 20 April 2011
Treat patients who have ingested too much paracetamol within eight hours of ingestion whenever possible
If the time of ingestion is known, treatment can be based on blood tests taken after four hours
If the timing is uncertain or unknown, treatment should be started immediately in all patients who are at potential risk.
Treat patients as high risk unless factors that increase risk of harm are known to be absent
paracetamol poisoning is common and potentially fatal.1 It is a leading cause of acute liver failure in the United Kingdom2 and the United States.3 Potential liver damage, predicted from blood paracetamol concentration and time from ingestion, can be prevented by prompt treatment with antidote. However, young and otherwise healthy patients still risk serious liver injury, especially if they present more than a few hours after overdose or take staggered overdoses over hours or days.
Therapeutic doses of paracetamol are mainly metabolised by conjugation to inactive metabolites. Paracetamol predominantly damages the liver. The reactive metabolite, N-acetyl-p-benzoquinoneimine (NAPQI), formed when paracetamol is oxidised by the cytochrome P450 enzyme family, is the key to hepatic injury. NAPQI binds covalently to sulphydryl groups, which can be provided by glutathione; but when glutathione stores are depleted NAPQI binds to cellular proteins .
Serious liver damage after a single 75 mg/kg body weight dose of paracetamol is rare, even in patients at increased risk.
In patients without risk factors, a dose less than 150 mg/kg body weight is unlikely to cause serious liver damage.
Severe paracetamol induced liver injury can be associated with renal failure.
Many patients who present do so within a few hours of taking an overdose, when symptoms and signs are absent or confined to nausea and vomiting. Lactic acidosis and coma can,exceptionally, occur soon after ingestion of massive amounts of paracetamol. Their presence usually implies mixed overdose.
Right upper quadrant tenderness is common in patients presenting with established liver damage.
Patients who present after 24 hours may already have signs of liver failure—hepatic tenderness, jaundice, impaired consciousness, asterixis, foetor hepaticus, and haemorrhage.
Overt liver failure can, however,be delayed for two or three days. It is important not to overlook paracetamol in those who have signs suggesting overdose with another agent.
The crucial investigations are the timed serum paracetamol concentration, to determine risk of liver damage, and tests of liver function (including prothrombin time or international
normalised ratio) and kidney function. These tests are needed to assess risk and monitor progress. Prognosis is worse if they are abnormal at presentation. Paracetamol concentration in
venous blood should be measured between four and 16 hours after ingestion of a single dose to allow the patient’s risk to be determined from the standard nomograms.
Values obtained earlier than four hours cannot be interpreted because absorption is not yet complete. Values taken after 16 hours may be high because of acute liver injury that delays paracetamol metabolism, or falsely reassuring, even though irreversible liver damage has already occurred. In untreated patients with negative tests for paracetamol and normal hepatic and renal function 24 hours after exposure, serious harm is unlikely.
Ketones on urinalysis and low blood urea concentration can indicate starvation or poor nutrition, which increases the risk
of liver damage.
Raised γ-glutamyl transpeptidase activity is apotentially useful indicator of hepatic enzyme induction.
Treatment depends on adequate assessment, first aid measures,and transfer of at risk patients for antidotal treatment. Activated charcoal taken soon after overdose should reduce absorption of
paracetamol. It is unlikely to help more than an hour after overdose.
Acetylcysteine
The mainstay of treatment for patients who have taken apotentially toxic dose of paracetamol is the antidote acetylcysteine, which is a sulphydryl donor. It is given intravenously in three sequential infusions, each containing adifferent dose of antidote, and is based on the patient’s body weight (up to a maximum dose equivalent to a weight of 110 kg) (table 2).
Acetylcysteine replenishes glutathione stores, which at least partly explains its antidotal efficacy. A large multicentre study of efficacy published in 1988 found that the antidote is uniformly effective if given within eight hours of a single overdose, but
subsequently its efficacy falls. A controlled trial provided evidence that acetylcysteine can improve outcome even inpatients with encephalopathy, so those who present more than eight hours after overdose are still treated with the antidote if they are deemed at risk of liver damage or if liver function is already abnormal.
A retrospective cohort study of more than 4000 patients showed that intravenous treatment is at least as effective as oral treatment but takes less time to administer. Intravenous treatment can be administered reliably even if the patient is vomiting.Findings from animal studies suggest that the alternative sulphydryl donor methionine is less effective than acetylcysteine
Treating adverse events related to
acetylcysteinecommonly causes vomiting when given by mouth or nausea when given intravenously. It can also provoke an anaphylactoid reaction, which is mediated
by histamine and depends on blood acetylcysteine
concentrations. Such reactions may be more common in patients with asthma, those with a family history of drug allergy, and women.Almost all reactions can be treated effectively by interrupting the acetylcysteine infusion and providing symptomatic relief with an antihistamine such as chlorphenamine and nebulised salbutamol if needed.
In severe reactions where the patient becomes haemodynamically unstable resuscitation may be needed. Once the reaction has subsided,however, ensure that the entire dose of acetylcysteine is given in due course, possibly at a slower rate of infusion (for example,at a rate of 50 mg/kg/h).
Acetylcysteine has, very rarely, been associated with fatal adverse reactions; some reported cases have been caused by miscalculation of the dose, which has led to overdose with the antidote.
The risk of an anaphylactoid reaction is higher in patients with lower plasma concentrations of paracetamol; this suggests that
treating patients who are unlikely to benefit from the antidote may increase the frequency of adverse reactions. Neither cost-benefit analysis, nor experience in Denmark, supports
a policy of universal treatment with acetylcysteine.
What supportive treatment should be given?
Fluid replacement and symptomatic treatment for nausea and vomiting are often needed. When acute liver failure has already occurred, or seems likely, intensive supportive treatment and—in the appropriate circumstances—liver transplantation will be needed. A transplant is most likely to be successful if the need for one is identified early, so swift referral is important (box 2).
How to manage the patient after administering the antidote
Liver damage can be detected by measuring international normalised ratio, serum creatinine concentration, and liver function at the end of acetylcysteine treatment; some units also measure paracetamol concentration because appreciable concentrations can indicate a risk of continuing damage.UK guidelines, which have extrapolated from the study of acetylcysteine in encephalopathy, suggest that if the international normalised ratio exceeds 1.3, or transaminases have increased to more than double baseline values, then the antidote should continue to be infused at a dose of 100 mg/kg over 16 hours until results are acceptable. Patients with renal dysfunction after paracetamol poisoning require ongoing monitoring and may need renal support.
Areas of uncertainty
The optimal dosage of acetylcysteine and the appropriate dose adjustment for body weight remain unclear and are difficult to study in patients. Because the initial rapid infusion seems to cause most adverse effects, some people advocate giving the loading dose over one hour, although this is of no confirmed benefit.Better indicators of prognosis both at presentation and as awarning of impending liver failure, and more secure criteria for liver transplantation, are needed.Drugs that prevent mitochondrial injury and drugs that target key inflammatory mediators have been shown to prevent injury from paracetamol in experimental models and represent potential new therapeutic targets.
The Carey Coombs murmur is a short mid-diastolic murmur caused by active rheumatic carditis with mitral-valve inflammation. The murmur is soft and low pitched, heard best at the apex. The murmur is frequently transient,with onset during acute rheumatic mitral valvulitis and improvement or resolution with recovery from the acute illness.
It is thought that the murmur is the result of turbulence caused by thickened mitral-valve leaflets. Although similar to the diastolic rumble of mitral stenosis, the Carey Coombs murmur does not have an opening snap, presystolic accentuation,or a loud first sound, but may follow an S3 gallop. The latter may be superficially confused with an opening snap.
Causes of generalised sweating
Infectious• Tuberculosis
• HIV
• Endocarditis
Endocrine
• Menopause*
• Hyperthyroidism*
• Phaeochromocytoma
• Carcinoid syndrome
• Acromegaly
• Diabetes
Neurological
• Parkinsonism
• Neuropathies
Malignancies
• Myeloproliferative disorders• Lymphoma
Medication
• Antidepressants* (SSRIs, especially vanlafaxine and tricyclics)
• Hormonal agents (tamoxifen, GnRH agonists)*
• Antipyretics (aspirin, NSAIDs)*
Intoxication*
Withdrawal from alcohol or other substances*
*Most common.
The AHA-ASA guidelines suggest that either extended-release dipyridamole plus aspirin
or clopidogrel monotherapy should be used over aspirin monotherapy.
Both guidelines recommend avoiding the combination of clopidogrel and aspirinfor most patients with previous stroke or TIA.
After a mean follow-up of 1.9 years, 939 (9.8%) of patients in the clopidogrel group experienced primary composite events compared with 1021 (10.7%) in the aspirin group. This resulted in an 8.7% relative risk reduction (95% confidence interval [CI] 0.3-16.5, p=0.043) for the primary composite end point, favoring clopidogrel. In terms of bleeding, intracranial hemorrhage or any bleeding disorder occurred similarly with clopidogrel versus aspirin, whereas gastrointestinal hemorrhage occurred more frequently in patients taking aspirin than in those taking clopidogrel.
The risks of minor, major, and life-threatening bleeding were each significantly increased in the aspirin clopidogrel group compared with aspirin monotherapy. Overall, there were nearly 3 times more reported bleeding events in the combination group than in the aspirin monotherapy group.
The combination of aspirin and clopidogrel should be reserved for those who have had coronary artery stenting.
Antithrombotic Agents
Aspirin 325 mg/day should begin within 24–48 hours of AIS therapy and is the only anti-thrombotic to receive a class I, level A rating.[3] Because previous stroke is a risk factor for another AIS event, patients may be taking aspirin, clopidogrel, or extended-release dipyridamole–aspirin at presentation.Although these agents should not be given within 24 hours of intravenous alteplase, their previous use does not preclude administration of intravenous alteplase.
Three efficacious treatments are available for hyperthyroidism.
Radioiodine therapy and surgeryare considered definitive therapies, since the primary goal of this approach to treatment is to
destroy hyperfunctioning thyroid tissue. Antithyroid drugs (methimazole, carbimazole, and propylthiouracil) are used in one of two ways.
On occasion before radioiodine administration
And usually before surgery, several weeks of treatment with an antithyroid drug is administered to achieve a euthyroid state. Antithyroid drugs are
also used in Graves’ hyperthyroidism for 1 to 2
years, or longer, with the hope of achieving a remission.
Remission of hyperthyroidism is not
expected when antithyroid drugs are used during
the long-term treatment of toxic adenoma or toxic
multinodular goiter;
in these cases, early definitive
therapy with radioiodine or surgery is indicated.
The antibiotic trimethoprim has structural and pharmacological similarities to the potassium sparing diuretic amiloride and reduces urinary potassium excretion by approximately 40%.
The inhibition of potassium secretion results in a dose related antikaliuretic effect that may predispose susceptible people to clinically important hyperkalaemia.
Trimethoprim-sulfamethoxazole induced hyperkalaemiain elderly patients receiving spironolactone:
BMJ22 July 2011
Prescription of trimethoprim-sulfamethoxazole to elderly patients receiving treatment with spironolactone was associated with a major increase in the risk of hyperkalaemia, and this risk greatly exceeded that observed with other commonly used antibiotics for urinary tract infection. Increased awareness of this drug interaction among pharmacists and physicians is needed to ensure that the potential for life threatening hyperkalaemia with this drug combination is minimised, either by selection of alternative antibiotics when appropriate or by close monitoring of patients treated with both drugs.
BMJ 22 July 2011
Ketonuria occurs in
diabetic ketoacidosis,starvation,
alcohol use and
very low carbohydrate diets.
Test is specific for aceto-acetate and does not detect other ketones, e.g. β-OH butyrate, acetone. False +ve may occur with highly concentrated urine.
Ketones
False +ve occurs with phenothiazines, contamination with detergents, chlorhexidine and alkalis.
False -ve occurs in acid preservative contamination and Bence Jones proteinuria (Ig light chains) in myeloma
Proteinuria
Bilirubinuria is not normally present.
False +ve occurs with phenothiazines, and false -ve with vitamin C intake
Hyaline casts are relatively clear, homogeneous cylindrical structures, consisting principally of Tamm-Horsfall mucoprotein secreted by tubular cells. seen with severe exercise, fever and chronic renal disease.
Granular casts are hyaline casts containing granules of albumin and immunoglobulin; they may also contain cellular debris. They are found in disorders associated with significant proteinuria, e.g. glomerulonephritis and diabetic nephropathy.
Red cell casts indicate haematuria of glomerular origin e.g. acute diffuse proliferative glomerulonephritis
White cell casts suggest renal infection or inflammation
Casts are cylindrical structures formed in the renal tubules
)NSAIDs
prevent the production of prostaglandins, molecules which dilate the afferent arteriole.
NSAIDs could therefore worsen kidney function by decreasing afferent blood flow to the Bowman's capsule.
The nephropathy that develops in type 2 DM differs from that of type 1 DM in the following respects:
• Microalbuminuria or macroalbuminuria may be present when type 2 DM is diagnosed, reflecting its long asymptomatic period;
• Hypertension more commonly accompanies microalbuminuria or macroalbuminuria in type 2 DM;
• Microalbuminuria may be less predictive of diabetic nephropathy and progression to macroalbuminuria in type 2 DM.
• Finally, it should be noted that albuminuria in type 2 DM may be secondary to factors unrelated to DM, such as hypertension, congestive heart failure, prostate disease, or infection.
• The kidneys have a special job to do , ie filtering the toxic molecules. The nephrons of the kidneys are probably the most “high – tech” cells in human body (Of course ,next only to brain cells ) .
• The vascular tuft of glomerulus located within the bowman’s capsule is perfused by afferent arteriole and drained by efferent arteriole .
The entry of blood into glomerulus is regulated both by afferent and efferent arteriolar tone .These two micro-circulaoty units are under the sensitive control of both neural and humoral signals. Glomerular circulation is meticulously regulated by renal juxta glomerular apparatus.It modulates the glomerular blood flow by secreting renin which acts through Anigiotensin 2 on the efferent arteriole .
The tone of the efferent arteriole is thought to be the single important factor in this servo control mechanism.
What happens in bilateral renal arterial stenosis ?
When there is bilateral renal arterial stenosis , the effective renal blood flow is not significantly reduced , but maintained at the cost of increasing the efferent arteriolar constrictor tone.It is like a check valve at the exit point of a dam , which is partially closed to maintain the adequate pressure head (Here , intra-glomerular pressure head )What happens when ACEI are introduced ?
Once ACE inhibitors administered , the efferent arteriolar tone is removed , this triggers the intra glomerular pressure to drop suddenly and filtration pressure reduces .Note: ACEI does not reduce the renal blood flow directly but the glomerular perfusion pressure drops hence precipitating acute renal function deterioration.
What is your comment about the reno-protective effects of ACEI ?
The medical science’s most crucial moments are , when we confront , two diagonally opposite views are being debated and both suggest , there is definite benefit for the patient ! Cardiologists and nephrologists were always made to believe , that ACEI are unfriendly to kidneys .But ,we now have evidence , ACEI is not an untouchable molecule in renal dysfunction.Lookin at a long term perspective , AT 2 increases the intra -glomerular hypertension and ACEI inhibitors reduce it.This protects the nephrons from hyper-filtration mode , that accelerates the glomerular injury . So , the current thinking seems to suggest ACEI has a definite role in arresting the progress of renal cell injury .
The only issue for ACEI is , it should not be continued if an ARF like picture sets in. (Acute deterioration ). Otherwise , in CRF at any basal level of serum creatinine , ACEI can be continued . Some think even an increase by few mg of creatinine can be allowed .
So the following can be a working guideline
ACEI can be started or continued at any level of creatinine in stable CKD with or without dialysisBut ,ACEIs need to be stopped in all of the following
• Acute renal failures
• Acute on chronic renal failure
• Accelerated elevation of creatinine (As in bilateral renal artery stenosis)
How much elevation of creatinine is allowed in CKD with ACEI ?
This is not answered yet .
Diabetes mellitus and angiotensin-converting enzyme inhibitors
Angiotensin-converting enzyme (ACE) inhibitors were the first class of antihypertensive drugs shown to reduce the vascular complications in those with diabetes independent of a reduction in blood pressure. The reno-protective effects of ACE inhibitors were not only seen in those with overt nephropathy (macroalbuminuria), but also extend to those with incipient nephropathy (microalbuminuria), even in the absence of hypertension.A slow deterioration in renal function is not a contraindication to the use of ACE inhibitors in patients with renal insufficiency, but a rapid progressive rise in serum creatinine following initiation of ACE inhibitors should trigger immediate discontinuation of the agent and further evaluation of the patient for advanced renovascular disease.
Several of the reno-protective effects of ACE inhibitors have been related to the increase in kinins that occurs with these agents, which is also responsible for some of the side-effects associated with ACE inhibitor therapy such as a dry cough. Renal protection is related to the antihypertensive effects of ACE inhibitors in both normal and hypertensive patients: renal vasodilatation results in increased renal blood flow and dilatation of the efferent arterioles.
The history of ACE inhibitors In 1954, Skeggs and coworkers started to recognize substrates participating in the renin–angiotensin system. In 1956, they purified the enzyme responsible for the conversion of inactive angiotensin I to the active vasoconstrictor angiotensin II in the presence of chloride ions from horse plasma.
In 1968, Bakhle reported that BPF was a potent inhibitor of ACE from dog lung homogenate, and the long delayed purification of the active components of BPF was initiated by two groups – the first led by Ferreira in 1970 and the second led by Ondetti in 1971. Structure–activity correlation amongst the analogues of BPF suggested that these snake venom peptide inhibitors compete with substrates for binding to the active site of ACE.
By early 1974, the efficacy of ACE inhibitors as antihypertensive drugs had been demonstrated, but they were not yet available in an oral form for use in chronic hypertension. In the early 1980s, Squibb succeeded in developing an oral form known as captopril (Capoten) and received approval from the USA Food and Drug Administration for this drug. Since that time a number of other ACE inhibitors have been developed with differing pharmacokinetic qualities.
More recently, the development of the orally active angiotensin-receptor blockers (ARBs) has added an alternative way to inhibit the effects of angiotensin II. The superiority of ACE inhibitors in preventing the aggregate of major cardiovascular events has been demonstrated in two trials: one in which these agents were compared with diuretics/beta blockers and the other against a calcium antagonist.
The renin–angiotensin system The renin–angiotensin system is located mostly in the kidney and plays a major role in the homeostatic regulation of blood pressure, fluid and electrolytes. It is composed of both functional and anatomical aspects.
Functional aspects The functions of the renin-angiotensin system are mediated by a number of hormones and enzymes. Renin Renin is a glycoprotein synthesized as a long preprohormone composed of 406 amino acid residues. Active renin contains 340 amino acid residues and is exclusively produced by the kidneys, being formed in the secretory granules of the juxtaglomerular cells. It converts the plasma protein angiotensinogen to angiotensin I.
Angiotensinogen Angiotensinogen is a protein synthesized in the liver. It is composed of 453 amino acid residues with a characteristic 32 amino acid signal sequence that is removed in the endoplasmic reticulum. ACEACE (also known as kininase II) is a dipeptidyl carboxpeptidase that converts angiotensin I to angiotensin II. It is located mainly in endothelial cells. Bradykinin, one of the vasodilator hormones, is inactivated by the same enzyme. Most of the conversion of angiotensin I to angiotensin II occurs as the blood passes through the lungs, though it also takes place in many other parts of the body
Angiotensin I, II and III Angiotensin I is a physiologically inactive decapeptide that is produced by the action of renin on angiotensinogen. Angiotensin II is a physiologically active octapeptide known previously as hypertensin or angiotonin. It is rapidly metabolized in the circulation, having a half-life of 1-2 min. Angiotensin III is a physiologically active heptapeptide resulting from the metabolism of angiotensin II.
Anatomical aspects Angiotensin II receptorsThere are at least two classes of angiotensin II receptors (AT). The main type is angiotensin receptor-1 (AT1). The gene for this receptor is located on chromosome 3. AT2 is less important than AT1; its gene is located on chromosome X. The effect of these receptors differs from tissue to tissue. For example, the AT1 receptors in arterioles and those in the adrenal cortex are regulated in opposite directions: an excess of angiotensin II will downregulate the vascular receptors but upregulate the adrenal cortical receptors, making the gland more sensitive to aldosterone-stimulating hormone.
The AT1 receptor is classified into two subtypes. AT1A is located mainly in the blood vessel walls, the brain and other organs and mediates most of the known effects of angiotensin.20 AT1B is found in the anterior pituitary and adrenal cortex. AT2 receptors are more plentiful in fetal and neonatal life, but they persist in the brain and other organs in adults. AT2 receptors are important in fetal kidney development, modulation of pressure natriuresis, angiotensin II-induced renal production of nitric oxide, and the renal conversion of prostaglandin E2 to prostaglandin F2a.21 In addition, experimental evidence suggests that AT2 receptors may counterbalance some of the effects mediated by AT1 receptors.
The juxtaglomerular apparatus Renin is produced by the juxtaglomerular cells, which are epitheloid cells located in the media of the afferent arterioles as they enter the glomeruli. Renin is also found in the granular Lacis cells located at the junction between the afferent and efferent arterioles. The macula densa is a modified region of tubular epithelium located at the beginning of the distal convoluted tubule close to the juxtaglomerular cells. The juxtaglomerular cells together with the macula densa cells are known as the juxtaglomerular apparatus.
The renin–angiotensin system in diabetes mellitus There is increased stimulation of the sympathetic nervous system in diabetics compared with non-diabetics due to their need to increase the secretion of insulin from beta cells through stimulation of b2 receptors and to dilate the renal arterioles through stimulation of b1 and b2 receptors.
Dilatation of the renal arterioles occurs as a response to the pathological changes that develop in the kidney in diabetes. These vascular and interstitial changes eventually lead to deteriorating renal function. The development of diabetic nephropathy stimulates the renin–angiotensin system.
Poor diabetic control will further increase this stimulation.
It has also been shown that angiotensin may be present in abundance in some other tissues, including adipose tissue. In 1987, angiotensin mRNA was found in periaortal brown adipose tissue and in cells found within the rat aorta wall. Other studies have demonstrated evidence for the existence of an intrinsic angiotensin-generating system in the pancreas. Recent epidemiological data have shown that administration of ACE inhibitors in hypertensive patients may have a protective role in preventing the occurrence of diabetes. This epidemiological data may explain why some antidiabetic drugs such as thiazoladinedione can decrease blood pressure in obese diabetics.
Clinical recommendations concerning ACE inhibitors The clinical recommendations and guidelines of many medical and diabetic societies and associations include the use of ACE inhibitors in diabetes. The European Society of Hypertension – European Society of Cardiology guidelines for the management of arterial hypertension states that ACE inhibitors are indicated in the following conditions:
• congestive heart failure/left ventricular dysfunction
• post-myocardial infarction
• non-diabetic nephropathy
• type 1 diabetic nephropathy/proteinuria.
However, they recommend the use of an ARB in the following conditions:
• type 2 diabetic nephropathy• diabetic microalbuminuria
• proteinuria
• left ventricular hypertrophy
• ACE inhibitor-induced cough.
In the Canadian Hypertension Education Program recommendations, ACE inhibitors are recommended as part of the initial therapy for the following conditions:
• diabetes mellitus with or without nephropathy
• angina
• post-myocardial infarction
• heart failure
• post-cerebrovascular accident or transient ischaemic attack
• renal disease
• left ventricular hypertrophy.
The American Diabetes Association recommends that the use of an ACE inhibitor should be considered in all diabetic patients older than 55 years with or without hypertension, but with another cardiovascular risk factor
(a history of cardiovascular disease, dyslipidaemia, microalbuminuria or smoking).
A combination of an ACE inhibitor and an ARB can be used in the treatment of albuminuria and diabetic nephropathy.
The seventh Report of the Joint National Committee on Prevention, Detection, Evaluation and Treatment of High Blood Pressure recommends the use of ACE inhibitors in the following conditions:
hypertension with acute coronary syndromes such as unstable angina or myocardial infarction
post-myocardial infarction
heart failure
diabetic hypertension
chronic kidney disease (a limited increase in serum creatinine of as much as 35% above the baseline with ACE inhibitors or ARBs is acceptable unless hyperkalaemia develops)
cerebrovascular disease.
Clinical trials assessing the use of ACE inhibitors in diabetes In the following trials, patients with type 2 diabetes mellitus were randomized to receive ACE inhibitors as initial therapy and the outcome compared with that in patients receiving other antihypertensive drugs:
the UK Prospective Diabetes Study,27 which compared the effect of captopril versus atenolol
the MICRO-HOPE Diabetic substudy,28 part of the larger Heart Outcome Prevention Evaluation (HOPE) study, which compared the use of ramipril versus placebo
the Appropriate Blood Pressure Control in Diabetes (ABCD) trial,29 which compared the use of enalapril versus nisoldipine
the Captopril Prevention Project (CAPPP),30 which compared the use of captopril versus diuretic or b-blockers
the Fosinopril versus Amlodipine Cardiovascular Events Trial (FACET),31 which compared the use of fosinopril versus amlodipine.
Management of hypertension in African Americans All antihypertensive drug classes can be used by African Americans to lower their blood pressure; in terms of efficacy, there is no rationale for avoiding certain classes of agents on the grounds of race. However, when prescribing ACE inhibitors the clinician should bear in mind that African Americans appear to be at increased risk for ACE inhibitor-associated angio-oedema and cough compared with Caucasians.
Conclusion ACE inhibitors should be recommended for use in all diabetic patients, especially those with type 2 diabetes mellitus. They are useful not only as antihypertensive drugs but also provide renal protection.
Renal effects of ACE inhibitors in hypertension
INTRODUCTIONThe effect of angiotensin converting enzyme (ACE) inhibitors on renal function in the hypertensive patient is related both to the glomerular actions of angiotensin II and to the mechanism of autoregulation of the glomerular filtration rate (GFR) [1]. Angiotensin II constricts both the afferent and efferent arterioles, but preferentially increases efferent resistance [2]. At least three factors may contribute to this response:
The efferent arteriole has a smaller diameter in the basal state; as a result, further constriction at this site will produce a greater increase in resistance than at the afferent arteriole [2].
Angiotensin II stimulates the release of the vasodilator nitric oxide from the afferent arteriole, thereby minimizing constriction at this site .
Angiotensin II minimizes vasoconstriction at the afferent arteriole via the stimulation of angiotensin II type 2 receptors, which results in vasodilation through a cytochrome P-450 dependent pathway .
The net effect of the more prominent increase in efferent tone is that the intraglomerular pressure is stable or increased, thereby tending to maintain or even raise the GFR. In addition to these arteriolar actions, angiotensin II constricts the mesangial cells, an effect that tends to lower the GFR by decreasing the surface area available for filtration.
ANGIOTENSIN II AND AUTOREGULATION OF GFR
As the renal perfusion pressure is diminished (due for example to antihypertensive therapy), the kidney is initially able to maintain both blood flow and glomerular filtration via the phenomenon of autoregulation .The first part of the autoregulatory response is decreased afferent (precapillary) arteriolar tone, thereby allowing more of the systemic pressure to be transmitted to the glomerulus. Afferent dilatation is mediated both by tubuloglomerular feedback and by a direct myogenic response. With more marked reductions in renal perfusion pressure, renin release is stimulated; the ensuing increase in angiotensin II production maintains both intraglomerular pressure and the GFR via a preferential increase in resistance at the efferent arteriole .The net effect is that the GFR and renal blood flow do not begin to fall until these autoregulatory changes in arteriolar resistance are maximized.ESSENTIAL HYPERTENSION
In patients with essential hypertension, renal perfusion pressure is elevated and therefore maintenance of the GFR is not as dependent upon angiotensin II. As a result, an ACE inhibitor generally induces little change in GFR in patients who have normal renal function .In comparison, some patients with relatively recent onset hypertension have increased angiotensin II activity, renal vasoconstriction, and a GFR below 80 mL/min. In this setting, an ACE inhibitor can raise the GFR by 10 to 30 mL/min, presumably due to reversal of angiotensin II-induced mesangial contractionOximeters are easy to use, portable, non-invasive and inexpensive. They are widely used for the continuous measurement of SpO2 and to adjust oxygen therapy. In acutely ill patients with no risk of CO2 retention, SpO2 should be maintained at 94-98%. Movement artifact, poor tissue perfusion, hypothermia and nail varnish can lead to spuriously low SpO2 values. Dark skin pigmentation, and raised levels of bilirubin or carboxyhaemoglobin can result in false increases in SpO2. Oximetry is less accurate with saturations <75% and unreliable when peripheral perfusion is poor.
Pulse oximetry
Blood film Use in diagnosing Malaria
The preferred and most reliable diagnosis of malaria is microscopic examination of blood films, because each of the four major parasite species has distinguishing characteristics.Two sorts of blood film are traditionally used. Thin films are similar to usual blood films and allow species identification, because the parasite's appearance is best preserved in this preparation.
Thick films allow the microscopist to screen a larger volume of blood and are about eleven times more sensitive than the thin film, so picking up low levels of infection is easier on the thick film, but the appearance of the parasite is much more distorted and therefore distinguishing between the different species can be much more difficult.
From the thick film, an experienced microscopist can detect all parasites they encounter. Microscopic diagnosis can be difficult because the early trophozoites ("ring form") of all four species look identical and it is never possible to diagnose species on the basis of a single ring form; species identification is always based on several trophozoites.
The biggest pitfall in most laboratories in developed countries is leaving too great a delay between taking the blood sample and making the blood films. As blood cools to room temperature, male gametocytes will divide and release microgametes: these are long sinuous filamentous structures that can be mistaken for organisms such as Borrelia. If the blood is kept at warmer temperatures, schizonts will rupture and merozoites invading erythrocytes will mistakenly give the appearance of the accolé form of P. falciparum.
If P. vivax or P. ovale is left for several hours in EDTA, the build up of acid in the sample will cause the parasitised erythrocytes to shrink and the parasite will roll up, simulating the appearance of P. malariae. This problem is made worse if anticoagulants such as heparin or citrate are used. The anticoagulant that causes the least problems is EDTA. Romanowsky stain or a variant stain is usually used. Some laboratories mistakenly use the same staining pH as they do for routine haematology blood films (pH 6.8): malaria blood films must be stained at pH 7.2, or Schüffner's dots and James's dots will not be seen. There are different kinds of blood smears that identifies many kinds of parasites in blood.
Blood smear from a P. falciparum culture (K1 strain). Several red blood cells have ring stages inside them. Close to the center there is a schizont and on the left a trophozoite
Making thick and thin blood smears
• Whenever possible, use separate slides for thick and thin smears.
• Thin film (a): Bring a clean spreader slide, held at a 45° angle, toward the drop of blood on the specimen slide.
3. Thin film (b): Wait until the blood spreads along the entire width of the spreader slide.
4. Thin film (c): While holding the spreader slide at the same angle, push it forward rapidlyand smoothly.
5. Thick film: Using the corner of a clean slide, spread the drop of blood in a circle the size of a dime (diameter 1-2 cm). Do not make the smear too thick or it will fall off the slide. (You should be able to read newsprint through it.)
6. Wait until the thin and thick films are completely dry before staining. Fix the thin film with methanol (100% or absolute) and let it dry completely before staining. The thick film should not be fixed.
7. If both thin and thick films need to be made on the same slide, fix only the thin film with methanol. The thick film should not be fixed.
Prebiotics and probiotics can restore the balance of bacteria in your digestive tract. Probiotics are beneficial bacteria that can be found in various foods. When you eat probiotics, you will add these healthy bacteria to your intestinal tract. Common strains include Lactobacillis and Bifidobacterium families of bacteria.
Prebiotics are non-digestible foods that make their way through our digestive system and help good bacteria grow and flourish. Prebiotics keep beneficial bacteria healthy.
Prebiotics in the Diet:
feed the beneficial bacteria in your gut mostly come from carbohydrate fibers called oligosaccharides. You don't digest them, so the oligosaccharides remain in the digestive tract and stimulate the growth of beneficial bacteria. Sources of oligosaccharides include fruits, legumes, and whole grains. Fructo-oligosaccharides may be taken as a supplement or added to foods. Yogurt made with bifidobacteria contain oligosaccharides.Probiotics in the Diet:
Probiotic bacteria like lactobacilli are naturally found in fermented foods like sauerkraut and yogurt. Some foods will have added probiotics as healthy nutritional ingredients, which will be evident on the label.
Imipenem is an intravenous β-lactam antibiotic developed in 1980. It has an extremely broad spectrum of activity.
Imipenem belongs to the subgroup of carbapenems. It is derived from a compound called thienamycin, which is produced by the bacteria Streptomyces cattleya. Imipenem has a broad spectrum of activity against aerobic and anaerobic Gram positive as well as Gram negative bacteria. It is particularly important for its activity against Pseudomonas aeruginosa and the Enterococcus species. It is not active against methicillin-resistant Staphylococcus aureus.
Imipenem acts as an antimicrobial through inhibiting cell wall synthesis of various gram-positive and gram-negative bacteria. It remains very stable in the presence of beta-lactamase (both penicillinase and cephalosporinase) produced by some bacteria, and is a strong inhibitor of beta-lactamases from some gram-negative bacteria that are resistant to most beta-lactam antibiotics.
Imipenem/cilastatin (trade name Primaxin) is a broad spectrum beta-lactam antibiotic containing equal quantities of imipenem and cilastatin. It is related to the penicillin/cephalosporin family of antibiotics but is classified as belonging to the carbapenem class.
Mechanism
It works by interfering with their ability to form cell walls.Imipenem, the active antibiotic agent, is rapidly degraded by the renal enzyme dehydropeptidase if administered alone ,the metabolites can cause kidney damage.
Administration. It may be less likely to cause an allergic reaction in people who have had an allergic reaction to a penicillin in the past. It is particularly effective against Enterobacter species.
Cilastatin is a chemical compound which inhibits the human enzyme dehydropeptidase.
Dehydropeptidase is found in the kidney and is responsible for degrading the antibiotic imipenem. Cilastatin is therefore combined intravenously with imipenem in order to protect it from dehydropeptidase and prolong its antibacterial effect. However, cilastatin itself does not have antibiotic activity.
Another carbapenem, meropenem is resistant to dehydropeptidase; therefore, it can be given without cilastatin.
Imipenem/cilastatin
Common adverse drug reactions are nausea and vomiting. People who are allergic to penicillin and other beta-lactam antibiotics should take caution if taking imipenem as cross-reactivity rates are low.
At high doses imipenem is actually seizuregenic.
Conjugated monoclonal antibodies
Are monoclonal antibodies that are attached to drugs, toxins, or radioactive substances. The MAbs are used as homing devices to take these substances directly to the cancer cells. The MAb circulates in the body until it can find and hook onto the target antigen. It then delivers the toxic substance where it is needed most.This lessens the damage to normal cells in other parts of the body.
Conjugated antibodies may pack more of a punch than naked MAbs, but for this reason they often cause more side effects, too. The side effects depend on which type of substance they're attached to.
Conjugated MAbs are also sometimes referred to as tagged, labeled, or loaded antibodies. They can be divided into groups depending on what they are linked to.
MAbs with radioactive particles attached are referred to as radiolabeled, and therapy with this type of antibody is known as radioimmunotherapy (RIT).
MAbs with chemotherapy drugs attached are often referred to as chemolabeled.
MAbs attached to toxins are called immunotoxins
Roughly, transudates are a result of increased pressure in the portal vein(>8 mmHg, usually around 20 mmHg), e.g. due to cirrhosis, while exudates are actively secreted fluid due to inflammation or malignancy. As a result, exudates are high in protein, high lactate dehydrogenase , have a low PH (<7.30), a low glucose level, and more white cell .
Transudates have low protein (<30g/L), low LDH, high pH, normal glucose, and fewer than 1 white cell per 1000 mm³. Clinically,
the most useful measure is the difference between ascitic and serum albumin concentrations. A difference of less than 1 g/dl (10 g/L) implies an exudate.
Portal hypertension plays an important role in the production of ascites by raising capillary hydrostatic pressure within the splanchnic bed.
Regardless of the cause, sequestration of fluid within the abdomen leads to additional fluid retention by the kidneys due to stimulatory effect on blood pressure hormones, notably aldosterone. The sympathetic nervous system is also activated, and renin production is increased due to decreased perfusion of the kidney. Extreme disruption of the renal blood flow can lead to hepatorenal syndrome. Other complications of ascites include spontaneous bacterial peritonitis (SBP), due to decreased antibacterial factors in the ascitic fluid such as complement.
In gastroenterology, the puddle sign is a physical examination maneuver that can be used to detect the presence of ascites. It is useful for detecting small amounts of ascites -- as small as 120 mL; shifting dullness and bulging flanks typically require 500 mL.
Patient lies prone for 5 minutes
Patient then rises onto elbows and knees
Apply stethoscope diaphragm to most dependent part of the abdomen
Examiner repeatedly flicks near flank with finger. Continue to flick at same spot on abdomen
Move stethoscope across abdomen away from examiner
Sound loudness increases at farther edge of puddle
Sound transmission does not change when patient sits
In relation to auscultatory percussion, the puddle sign is more specific, but less sensitive.
Assessing for Ascites
A large belly with bulging flanks associated with an everted umbilicus suggests ascites, as normally, obesity protrudes forwards.This is a sensitive, but not very specific, sign.
Fluid-filled flank will be dull on percussion.
Abdominal pain has several possible mechanisms and clinical patterns and warrants careful clinical assessment. Be familiar with three broad categories of abdominal pain:
1-Visceral pain occurs when hollow abdominal organs such as the intestine or biliary tree contract unusually forcefully or when they are distended or stretched. Solid organs such as the liver can also become painful when their capsules are stretched. Visceral pain may be difficult to localize. It is typically, though not necessarily, palpable near the midline, at levels that vary according to the structure involved, as illustrated on the next page.
Visceral pain varies in quality and may be gnawing, burning, cramping, or aching.
When it becomes severe, it may be associated with sweating, pallor, nausea, vomiting, and restlessness.
2- Parietal pain originates in the parietal peritoneum and is caused by inflammation.
It is a steady aching pain that is usually more severe than visceral pain and more precisely localized over the involved structure.
It is typically aggravated by movement or coughing. Patients with this type of pain usually prefer to lie still.
Abdominal tenderness occurs as a result of irritation of the parietal peritoneum. While inflammation or irritation of the visceral peritoneum will cause abdominal discomfort, anorexia, and poorly localized pain, it will not cause tenderness and rigidity of the abdominal wall. Irritation or inflammation of the parietal peritoneum will stimulate the pain fibers of the parietal peritoneum and abdominal wall, creating the symptoms of localized pain and the signs of tenderness, rigidity, and rebound tenderness. Thus, if there is diffuse irritation of the peritoneum, as in diffuse peritonitis, there will be diffuse tenderness and rigidity.
3-Referred pain is felt in more distant sites, which are innervated at approximately the same spinal levels as the disordered structure. Referred pain often develops as the initial pain becomes more intense and thus seems to radiate or travel from the initial site. It may be felt superficially or deeply but is usually well localized.
Pain may also be referred to the abdomen from the chest, spine, or pelvis, thus complicating the assessment of abdominal pain.
The abdominal wall skin should be inspected carefully for abnormalities.
Cullen's and Grey Turner's signs (bluish discoloration of the umbilicus and flanks, respectively) are related to intra-abdominal and retroperitoneal bleeding, and it is believed the blood dissects along fascial planes to reach these areas. Thus, one would want to question the patient diligently for causes of such bleeding—severe pancreatitis, trauma, or ruptured ectopic pregnancy.The skin should be inspected for striae, or "stretch marks," and surgical scars. The skin of the abdomen should also be checked carefully for engorged veins in the abdominal wall and the direction of blood flow in these veins. This is performed by placing the tips of the index fingers together, compressing a visible vein. The fingertips are then slid apart, maintaining compression, producing an empty venous segment between the fingers. A finger is removed from one end and the vein is watched for filling. The procedure is then repeated, but the opposite finger is removed and the vein again checked for filling.
Above the umbilicus, blood flow is normally upward; below the umbilicus, it is normally downward.
Obstruction of the inferior vena cava will cause reversal of flow in the lower abdomen.
In addition to these large dilated veins, note should be made of any spider angiomas of the abdominal wall skin.
Dynamic auscultation:
respiration:right sided murmurs are louder during inspiration
expiration has the opposite effect
squatting:
Increases venous return and peripheral resistance and results in almost all murmurs becoming louder the exception is in hypertrophic, obstructive cardiomyopathy where the dilatation of the left ventricle partially relieves the outflow obstruction
Valsalva manoeuvre:
this is expiration against a closed glottisThe patient is asked to hold his nose with his fingers, close his mouth and to breath out maximally (like straining at passing stool).
mitral prolapse - murmur elongated
aortic stenosis - murmur softer
mitral regurgitation - murmur becomes softer hypertrophic cardiomyopathy - murmur louder
During treatment of TB, patients should be monitored for drug toxicity. The most common adverse reaction of significance is hepatitis. Patients should be carefully educated about the signs and symptoms of drug-induced hepatitis (e.g., dark urine, loss of appetite) and should be instructed to discontinue treatment promptly and see their health care provider should these symptoms occur. Although biochemical monitoring is not routinely recommended, all adult patients should undergo baseline assessment of liver function (e.g., measurement of serum levels of hepatic aminotransferases and serum bilirubin).
Older patients, those with concomitant diseases, those with a history of hepatic disease (especially hepatitis C), and those using alcohol daily should be monitored especially closely (i.e., monthly), with repeated measurements of aminotransferases, during the initial phase of treatment. Up to 20% of patients have small increases in aspartate aminotransferase (up to three times the upper limit of normal) that are not accompanied by symptoms and are of no consequence.
For patients with symptomatic hepatitis and those with marked (five- to sixfold) elevations in serum levels of aspartate aminotransferase, treatment should be stopped and drugs reintroduced one at a time after liver function has returned to normal.
Hypersensitivity reactions usually require the discontinuation of all drugs and rechallenge to determine which agent is the culprit. Because of the variety of regimens available, it is usually not necessary—although it is possible—to desensitize patients. Hyperuricemia and arthralgia caused by pyrazinamide can usually be managed by the administration of acetylsalicylic acid; however, pyrazinamide treatment should be stopped if the patient develops gouty arthritis.
Individuals who develop autoimmune thrombocytopenia secondary to rifampin therapy should not receive the drug thereafter. Similarly, the occurrence of optic neuritis with ethambutol is an indication for permanent discontinuation of this drug. Other common manifestations of drug intolerance, such as pruritus and gastrointestinal upset, can generally be managed without the interruption of therapy.
Which patients diagnosed with type 1 diabetes should be referred for genetic testing?
Patients with MODY who present at a young age may be
misdiagnosed as having type 1 diabetes and inappropriately
treated with insulin.
In type 1 diabetes, autoimmune destruction of the β cells results in complete insulin deficiency within three to five years of diagnosis (the “honeymoon period”), whereas some β cell function is maintained in MODY. Consider MODY in patients with evidence of continued endogenous insulin secretion (for example, persistent C peptide production, low insulin dose (<0.5 units/kg/day), and no tendency to ketoacidosis when insulin is omitted) three to five years after diagnosis with apparent type 1 diabetes.
Evidence of continued endogenous insulin secretion (for example,
• persistent C peptide production,• low insulin dose (<0.5 units/kg/day), and
• no tendency to ketoacidosis when insulin is omitted) .
Which patients diagnosed with type 2 diabetes should be referred for genetic testing?
In contrast to type 2 diabetes, patients with MODY have β cell dysfunction that typically occurs in the absence of insulin resistance. Thus, patients with young onset (<45 years) of apparent type 2 diabetes, who do not have features of insulin resistance, may have MODY. Clinical features such as• acanthosis nigricans,
• central obesity,
• hypertension, and
• dyslipidaemia can be used as surrogate markers of insulin resistance in everyday clinical practice.
In contrast to type 2 diabetes, patients with MODY have β cell dysfunction that typically occurs in the absence of insulin resistance.
Clinical features such as
• acanthosis nigricans,• central obesity,
• hypertension, and
• dyslipidaemia can be used as surrogate markers of insulin resistance
The preferred tests for H pylori are 13C urea breath test or stool antigen test, as serology is less specific and cannot confirm eradication.
These tests are best done before starting proton
pump inhibitor, as a two week washout is needed after taking these drugs before testing by either method. If H pylori testing is positive, prescribe eradication therapy. Review at four weeks and re-test if symptoms persist. If H pylori persists, prescribe an alternative eradication regimen.
Dyspepsia
Red flags
• Evidence of gastrointestinal bleeding (change in bowel habit/stool colour, anaemia)• Unintentional weight loss
• Recurrent vomiting
• Dysphagia
• Abdominal mass
Dyspepsia
Long term use of proton pump inhibitors for recurrent symptoms without red flags
is safe, but because of their cost and small associated risk of infectious complications or nutritional deficiencies they should be prescribed at the lowest dose for the shortest period necessary.Dyspepsia
In patients younger than 55 presenting with dyspepsia without red flags, routine endoscopy is unnecessary, because the chances of having upper gastrointestinal cancer are estimated at one in a million. Refer patients if:
Red flags present in history or examination
Older than 55 with new onset persistent dyspepsia despite lifestyle and drug modification and four weeks’ treatment
Younger than 55 and symptoms unresponsive to full dose pump inhibitors, H pylori eradication, and lifestyle modifications where concern exists about diagnosis.
Dyspepsia
Learning bite
You should always review the medication sheet in patients following a myocardial infarction. Some cardiac drugs are contraindicated following a myocardial infarction. These include:
• Flecainide
• Calcium channel blockers like nifedipine
• Sotalol.
Aspirin, a beta blocker, statin, and ACE inhibitor after a myocardial infarction
The patient should stay on these treatments indefinitely.The treatment durations for which there is at least one trial that provides direct support are1:
Three and a half years for antiplatelet drugs
Four years for beta blockers and ACE inhibitors
Six years for statins.
In the absence of a clear reason to stop treatment, it is reasonable to continue treatment indefinitely.
Care of patients after a myocardial infarction
Bupropion is another option for patients who want to stop smoking. But it is contraindicated in patients with a history of seizures, eating disorders, or any condition that increases a person's risk of seizures.
For patients in whom bupropion is indicated and safe, you should start it one to two weeks before the target date for stopping. Patients should, therefore, smoke and take bupropion at the same time for the first one to two weeks.
A third of all cancers in the UK are potentially Preventable.A third (more than 100 000 cases) of all cancers in the United Kingdom are caused by just four risk factors and are potentially preventable, concludes a comprehensive review of the evidence.
The researchers estimated that 106 845 cancers in the UK in 2010 were associated with smoking, poor diet, alcohol, and excess weight. And when all 14 lifestyle and environmental risk factors were included, this figure rose to 134 000 or (43% of the total).
BMJ 6 December 2011
The review, published as a supplement in the British Journal of Cancer ,found that 45% of all cancers in men and 40% in women could be prevented. The review looked at all the available evidencetogether with the latest (2010) estimates of cancer incidence.
The study’s lead author, Max Parkin, a Cancer Research UK epidemiologist who is based at Queen Mary college, University of London, said, “Leading a healthy lifestyle won’t guarantee you won’t get cancer, but doing so can greatly stack up the odds in your favour.” He added: “
Nine out of 10 lung cancer cases can be prevented.
Half of all colorectal cancers are due to the main four risk factors.”
The most important lifestyle risk factor for men and for women is smoking—causing 23% of cancers in men and 15.6% in women. Harpal Kumar, chief executive of the Cancer Research Campaign, said, “Smoking is still the biggest priority to tackle in terms of cancer prevention. The rates did come down substantially but have now plateaued, so we need to do much more. We need to get the message across that smoking is notjust a risk factor for lung cancer but other cancers too.”
For women, being overweight was shown to have a greater effect than drinking alcohol. The percentage of cancers in women linked to overweight and obesity was 6.9%, double the 3.3% for alcohol. “Being overweight is a clear risk factor for breast cancer, and because breast cancer is so common, that makes it higher in the ranking,” said Professor Parkin. Infections such as human papillomavirus were linked to 3.7% of cancers
in women, excessive sun exposure and sunbeds to 3.6%, and lack of fruit and vegetables to 3.4%.
For men, the next biggest risk factor, after smoking, was a lack of fruit and vegetables, at 6.1%.
Occupational risks, such as exposure to asbestos, was linked to 4.9% of cancers in men.
Alcohol was linked to 4.6% of cancers and being overweight or obese to 4.1%.“Like most healthcare systems in the world we focus adisproportionate amount on treatment rather than prevention,’said Dr Kumar. “If we could prevent 134 000 cases of cancer a year that would be an enormous saving for the NHS.”
Time to reconsider NICE guidance on heparin
prophylaxis in medical inpatients Domnick Felix D’Costa consultant physician Royal Wolverhampton Hospital, UKThe recent clinical practice guideline on venous
thromboembolism prophylaxis from the American College of Physicians indicates that for every 1000 patients treated the absolute benefit is a reduction of three pulmonary embolisms but with an absolute increase of nine haemorrhages, four of them major.
BMJ 6 December 2011
There is thus no net benefit and no significant
reduction in mortality.
Are we as doctors thus unwittingly doing medical inpatients more harm than good in prescribing heparin prophylactically according to diktat? We probably do more harm, particularly in patients staying longer than two weeks because they receive heparin for longer than the two weeks used in trials. Our anecdotal experience has been an increase in haemorrhages.Perhaps an open debate or an editorial in the BMJ is needed to raise awareness among doctors lest we fail on the first principle of the practice of medicine: primum non nocere
Patients taking tetracycline or quinolones need to avoid antacids and milky foods because the effects of these antibiotics can be reduced or even abolished if admixture occurs in the gut.
Once enzyme induction has occurred, the effect can continue for seven to 14 days after the inducing agent has been removed.
Carbimazole acts by blocking the uptake of iodine into the thyroid gland. Therefore it will stop the uptake of radioactive iodine and prevent it working. So you should stop the carbimazole one or two weeks before and after taking the radioactive iodine.
Obstructive shock caused by
• pulmonary embolism,• tension pneumothorax, or
• cardiac tamponade.
Features of dehydration can be subtle and physiological mechanisms may maintain fairly normal pulse and blood pressure when the patient is lying down. However, a postural fall in blood pressure is one of the most sensitive markers of intravascular depletion (provided the patient doesn't have autonomic neuropathy or isn't taking vasodilating drugs).
What is the most sensitive marker of volume depletion?
Tachycardia , Reduced skin turgor, Postural hypotension or Low jugular venous pressure?
• Patient develops oliguria despite fluid replacement and blood transfusion. What urinary biochemistry would suggest persistent hypovolaemia rather than established acute renal failure?
Urine sodium 5 mmol/l = ok =Oliguria with urine low in sodium and high in concentration suggests a strong physiological response to dehydration. The kidney is appropriately retaining sodium and water to maintain the circulating volume.
Urine specific gravity <1010
This option suggests that the patient has developed established acute renal failure. The kidneys have lost the ability to fully concentrate urine and are producing a low volume of "poor quality" urine.
Urine osmolality 320 mmol/l
This option suggests that the patient has developed established acute renal failure. The kidneys have lost the ability to fully concentrate urine.Urine urea 84 mmol/l
This option suggests that the patient has developed established acute renal failure. The kidneys have lost the ability to fully concentrate urine and are producing a low volume of "poor quality" urine, rather than the oliguria being due to intense urinary concentration as a physiological response to hypovolaemia.
you should restrict this patient's fluid intake. Sodium restriction is important for reducing thirst, and for fluid intake and retention albumin infusion to correct hypoalbuminaemia
An albumin infusion is unhelpful unless there is severe intravascular volume depletion and hypotension or acute renal failure. Administered albumin is rapidly lost in urine and so its effect is transient. Additional protein intake is unlikely to improve serum albumin levels, but the patient needs enough protein to avoid malnutrition.
Nephrotic syndrome
The newer proton pump inhibitors (lansoprazole, rabeprazole, pantoprazole, and esomeprazole) have a similar efficacy to omeprazole for controlling heartburn, healing rates, and relapse. Diarrhoea, nausea, and vomiting are among the most common side effects of proton pump inhibitors. Theophylline, isosorbide mononitrate and Nifedipine, may reduce the lower oesophageal sphincter tone.Gastro-oesophageal reflux
The tremor and shuffling gait both suggest parkinsonism. Dopaminergic antagonists (for example metoclopramide) are well known causes of parkinsonism. You should therefore withdraw the metoclopramide: the parkinsonian symptoms should then resolve.
Prothrombin complex concentrates may cause or exacerbate disseminated intravascular coagulation. Thrombogenicity and disseminated intravascular coagulation are almost certainly dose related problems. Prothrombin complex concentrates are subjected to virus inactivation and so are unlikely to transmit viruses. Prothrombin complex concentrates are potentially thrombogenic.
Haemolytic anaemia is the most common side effect of ribavirin.
What laboratory findings are suggestive of chronic malabsorption?Features that are consistent with malabsorption in the context of chronic diarrhea include elevated fecal fat (normal range, <20%), anemia with thrombocytosis (suggesting iron deficiency), an elevated prothrombin time (suggesting vitamin K deficiency), macroovalocytes (suggesting vitamin B12 deficiency), a low-normal serum albumin level (consistent with protein loss or poor synthesis), and low total blood calcium and phosphorus levels.
What are the most common infectious causes of chronic diarrhea?
A. Infectious causes of chronic diarrhea are usually protozoal, although bacterial overgrowth of the small intestine should be considered, as should chronic Clostridium difficile colitis and campylobacteriosis.Infection with microsporidia can result in chronic diarrhea, although usually in persons who have advanced acquired immunodeficiency syndrome or who are severely immunocompromised with other cell-mediated deficiencies.
Chronic intestinal cryptosporidiosis and cystoisosporiasis could easily result in a wasting illness and chronic diarrheal process, but severe disease is usually be seen in persons with compromised cellular immunity, such as those with advanced HIV infection, although Cystoisospora belli(also known as Isospora belli) infection can cause chronic diarrhea in immunocompetent persons, where peripheral eosinophilia is often present. Intestinal amebiasis and balantidiasis can also cause chronic diarrhea. Chronic giardiasis caused by Giardia lamblia can cause chronic secretory diarrhea with malabsorption and does not require an underlying immunocompromised state.
Clinical Pearls
What is the natural history of atrial fibrillation?Atrial fibrillation is usually a progressive disease. The natural history often begins with infrequent episodes of limited duration, termed “paroxysmal atrial fibrillation.” Such episodes then tend to become more frequent and longer in duration, progressing to persistent atrial fibrillation (which fails to terminate spontaneously within seven days and may require cardioversion) or permanent atrial fibrillation (if the arrhythmia lasts for more than one year and cardioversion either has not been attempted or has failed).
Persistent atrial fibrillation
(which fails to terminate spontaneously within seven days and may require cardioversion)Permanent atrial fibrillation
(if the arrhythmia lasts for more than one year and cardioversion either has not been attempted or has failed).
What is the comparative efficacy of radiofrequency catheter ablation and antiarrhythmic therapy for the treatment of atrial fibrillation?
Several randomized trials have demonstrated superior outcomes of radiofrequency ablation compared to antiarrhythmic drug therapy. In one trial, 198 patients with paroxysmal atrial fibrillation who had previously failed antiarrhythmic drug therapy were randomly assigned to either radiofrequency ablation or antiarrhythmic drug therapy with other agents. At 1 year, 86% of patients assigned to catheter ablation and 22% of patients assigned to antiarrhythmic drug therapy had not had a recurrent atrial tachyarrhythmia (P<0.001). Cardiovascular hospitalizations were also less frequent in the ablation arm
Morning Report Questions
Q. What are the indications for catheter ablation for atrial fibrillation?A. Catheter ablation is indicated to prevent recurrence of symptomatic atrial fibrillation in patients in whom medical therapy has been ineffective.
Ablation is most effective in patients with paroxysmal atrial fibrillation and less effective in patients with persistent atrial fibrillation, heart failure, or valvular disease. The desire to stop oral anticoagulation alone is not a valid indication to refer a patient for atrial fibrillation ablation.
Q. What are potential complications of catheter ablation?
A. Cardiac tamponade due to perforation is a potentially life threatening complication occurring in approximately 1.3% of patients. Direct injury can also occur to the phrenic nerve as a result of ablation near the right superior pulmonary vein and superior vena cava. Such injury can cause diaphragmatic paralysis.Esophageal injury has been reported in approximately 10% of patients; atrioesophageal fistulae are rare (0.04%) but can be devastating and even lethal. Cerebrovascular thromboembolism has been reported to occur in up to 2% of patients. Pulmonary vein stenosis is a late complication of ablation caused by injury to the pulmonary vein musculature. The reported incidence varies from 0 to 10%.
If your patient is hypercalcaemic parathyroid hormone should be suppressed completely, unless there is primary or tertiary hyperparathyroidism. Even a normal parathyroid hormone level (that is not suppressed) in the presence of hypercalcaemia should make you think about primary or tertiary hyperparathyroidism.
Secondary hyperparathyroidism can be prevented using calcitriol. Calcitriol is standard treatment for patients with chronic renal failure. Myeloproliferative disorders, such as essential thrombocythaemia, can cause artefactual hypercalcaemia
Thyrotoxicosis can cause hypercalcaemia
This is an unusual complication of hyperthyroidism, probably related to accelerated bone turnover and consequent release of calcium.A PaO2 of <7.3 kPa on two separate occasions, or a PaO2 of <8.0 kPa with secondary polycythaemia or clinical and/or echocardiographic evidence of pulmonary hypertension fulfils the criteria for long term oxygen therapy.
Smoking is associated with a decrease in risk of subclinical or clinical hypothyroidism among women current and former smokers, as compared to never smokers.
Leg ultrasound is only up to about 50% sensitive for detecting deep vein thrombosis. Venography is about 60% sensitive.
a : Peptic ulcer
A peptic ulcer is the most common cause of upper gastrointestinal haemorrhage - accounting for about 35% to 50% of episodes.b : Gastric and duodenal erosions
Gastric and duodenal erosions account for about 8% to 15% of episodes.
c : Oesophagitis
Oesophagitis accounts for about 5% to 15% of episodes.
d : Mallory-Weiss syndrome
Mallory-Weiss syndrome accounts for about 15% of episodes.
Contraindicated with allergy to nitrates, severe anemia, early MI, head trauma, cerebral hemorrhage, hypertrophic cardiomyopathy, pregnancy (Category C), lactation.
Use cautiously
with hepatic or renal disease, hypotension or hypovolemia, increased intracranial pressure, constrictive pericarditis, pericardial tamponade, low ventricular filling pressure or low PCWP.
Nitroglycerin
Nitrates: Administered by the sublingual (under the tongue), buccal (between the cheek and gum), oral, IV, or transdermal route; nitroglycerin administered: by the sublingual, buccal, topical, transdermal, oral, or IV route; if the buccal form of nitroglycerin prescribed: instruct the patient to place the buccal tablet between the cheek and gum or between the upper lip and gum above the incisors and allow it to dissolve.
Promoting an optimal response to therapy
Nitrates (cont’d): Nitroglycerin also administered by a metered spray canister to abort an acute anginal attack; instruct the patient to call the nurse if pain not relieved in three doses.Administering topical nitroglycerin: Dose measured in inches or millimeters; before measuring and applying the drug obtain patient’s blood pressure and pulse rate: compare with baseline and previous vital signs, if blood pressure lower, or pulse rate higher- contact primary health care provider before applying.
Administering topical nitroglycerin (cont’d): Applicator paper supplied with drug; one paper per application; express the prescribed amount of ointment onto paper, while holding the paper; remove paper from previous administration and cleanse area; rotate application sites to prevent inflammation of skin
Administering transdermal nitroglycerin (cont’d): Patients using patches prone to tolerance- nitroglycerin released at constant rate, steady plasma concentration maintained; when applying transdermal system: Inspect skin site- dry, free of hair, and not subject to excessive rubbing or movement; discuss the nursing interventions when applying transdermal system on the patient
Sublingual and intravenous nitroglycerin have not been studied during breastfeeding. Observe infants for flushing and discomfort after breastfeeding.
Nitrates/Nitrites.
Action/Kinetics:Sublingual, chewable. Onset: 2-5 min; duration: 1-3 hr. Oral Capsules/Tablets. Onset: 20-40 min; duration: 4-6 hr. Extended-release. Onset: up to 4 hr; duration: 6-8 hr.Additional Uses:Diffuse esophageal spasm. Oral tablets are only for prophylaxis while sublingual and chewable forms may be used to terminate acute attacks of angina.
Special Concerns:Use with caution during lactation. Safety and efficacy have not been established in children.
Additional Side Effects:Vascular headaches occur especially frequently. Pregnancy Category: C
Classes of Drugs Used to Treat Angina
Vasodilators (dilate arteries and veins): Calcium-channel blockers, NitrodilatorsCardioinhibitory drugs (reduce heart rate and contractility): Beta-blockers, Calcium-channel blockers
Ranolazine (FDA approved 1/06 - blocker of late sodium currents)
Anti-thrombotic drugs (prevent thrombus formation): Anticoagulants
• Indications
• Sublingual, translingual preparations: Acute angina
• Oral SR, sublingual, topical, transdermal, translingual, transmucosal preparations: Prophylaxis of angina
• IV: Angina unresponsive to recommended doses of organic nitrates or beta-blockers
• IV: Perioperative hypertension
• IV: CHF associated with acute MI
• IV: To produce controlled hypertension during surgery
• Unlabeled uses: Reduction of cardiac workload in acute MI and in CHF (sublingual, topical); adjunctive treatment of Raynaud's disease (topical)
Nitroglycerin
The bad news is that there are several risk factors for CAD, and most of them are common in Western societies. The good news is that most of these risk factors are things we have the ability to control. So we ourselves have a lot to say about how likely we are to have a heart attack.
The risk factors for heart attack can be divided into two general groups - those which we have no control over, and those which we can control.
Non-controllable Risk Factors
Non-controllable risk factors are risk factors we cannot do anything about. Generally, these risk factors are related to age, sex and genes.A family history of premature CAD (generally, CAD that has occurred in male relatives before the age of 50, or in female relatives before the age of 60.)Age 55 or older (men), or 65 or older (women)
For women, being post-menopausal, or having your ovaries removed.
Chronic kidney disease.
Controllable Risk Ractors
Controllable risk factors are risk factors under our control.
Controllable Risk Ractors
Controllable risk factors are risk factors under our control. Even though you can't do much about your age, sex, or genes, you can greatly diminish your risk of heart attack by paying careful attention to the following risk factors:
Smoking.
High cholesterol.
Obesity. Lack of exercise.
Hypertension. High blood pressure is a major risk factor for heart attack, and especially stroke.
Diabetes. - greatly accelerates the development of atherosclerosis.
Metabolic syndrome. closely related to diabetes, and in fact can be thought of as a sort of pre-diabetes. It, too, is strongly associated with the development of atherosclerosis.
Increased c-reactive protein (CRP). CRP is a relatively "new" risk factor. Increased levels of CRP indicate active inflammation somewhere in the body, and unless some obvious source of inflammation is seen elsewhere (such as active arthritis), elevated CRP is thought to reflect inflammation in the blood vessels - which goes along with atherosclerosis.
Lack of moderate alcohol intake. Several studies suggest that moderate alcohol intake (one to two drinks per day, or in some studies, one to two drinks per week) is associated with a reduced risk of heart attack. The reason doctors are reluctant to recommend alcohol for cardiac risk reduction is that, when people drink more than about two drinks per day, their overall risk of death (from liver disease, heart disease, breast cancer, trauma, and other causes) rises very quickly. And as we all know, for many people it's hard to stop with one or two.
Psychological stress. Stress has been linked to heart attacks for many years. But some stress in life is unavoidable - and is even a good thing in many cases.
Additional Risk Factors in Women
Here are two more risk factors that are specific to women:Taking birth control pills, especially among smokers. Birth control pills have been associated with a small increase in the risk of early heart attack in women. But when birth control pills are combined with smoking, there is a very large increase in risk. In fact, doctors should recommend that women who smoke should not take birth control pills.Complicated pregnancy. Women who develop certain complications during pregnancy - specifically, women who develop high blood pressure (a condition called preeclampsia) or diabetes during pregnancy, or who deliver low-birth-weight babies - have an increased risk of early heart attack. Because complicated pregnancies identify women who are at increased risk, these women should manage all their controllable risk factors very aggressively.
Typical progression
Sometimes the earliest presentation of acute myocardial infarction is the hyperacute T wave, which is treated the same as ST segment elevation.[9] In practice this is rarely seen, because it only exists for 2–30 minutes after the onset of infarction.[10] Hyperacute T waves need to be distinguished from the peaked T waves associated with hyperkalemia.In the first few hours the ST segments usually begin to rise. Pathological Q waves may appear within hours or may take greater than 24 hr. The T wave will generally become inverted in the first 24 hours, as the ST elevation begins to resolve.
Long term changes of ECG include persistent Q waves (in 90% of cases) and persistent inverted T waves. Persistent ST elevation is rare except in the presence of a ventricular aneurysm.
Differences in systolic blood pressure (SBP) of 10 mm Hg or more or 15 mm Hg or more between arms have been associated with peripheral vascular disease and attributed to subclavian stenosis. A difference in SBP of 10 mm Hg or more, or of 15 mm Hg or more, between arms might help to identify patients who need further vascular assessment. A difference of 15 mm Hg or more could be a useful indicator of risk of vascular disease and death.
Most patients with angina pectoris report of retrosternal chest discomfort rather than frank pain. The former is usually described as a pressure, heaviness, squeezing, burning, or choking sensation. Anginal pain may be localized primarily in the epigastrium, back, neck, jaw, or shoulders. Typical locations for radiation of pain are arms, shoulders, and neck. Typically, angina is precipitated by exertion, eating, exposure to cold, or emotional stress. It lasts for approximately 1-5 minutes and is relieved by rest or nitroglycerin.
Chest pain lasting only a few seconds is not usually angina pectoris. The intensity of angina does not change with respiration, cough, or change in position.
Pain above the mandible and below the epigastrium is rarely anginal in nature.
Myocardial ischemia develops when coronary blood flow becomes inadequate to meet myocardial oxygen demand. This causes myocardial cells to switch from aerobic to anaerobic metabolism, with a progressive impairment of metabolic, mechanical, and electrical functions. Angina pectoris is the most common clinical manifestation of myocardial ischemia.
It is caused by chemical and mechanical stimulation of sensory afferent nerve endings in the coronary vessels and myocardium.
Heart rate, myocardial inotropic state, and myocardial wall tension are the major determinants of myocardial metabolic activity and myocardial oxygen demand. Increases in the heart rate and myocardial contractile state result in increased myocardial oxygen demand. Increases in both afterload (ie, aortic pressure) and preload (ie, ventricular end-diastolic volume) result in a proportional elevation of myocardial wall tension and, therefore, increased myocardial oxygen demand.
Oxygen supply to any organ system is determined by blood flow and oxygen extraction.
Because the resting coronary venous oxygen saturation is already at a relatively low level (approximately 30%), the myocardium has a limited ability to increase its oxygen extraction during episodes of increased demand. Thus, an increase in myocardial oxygen demand (eg, during exercise) must be met by a proportional increase in coronary blood flow.The ability of the coronary arteries to increase blood flow in response to increased cardiac metabolic demand is referred to as coronary flow reserve (CFR). In healthy people, the maximal coronary blood flow after full dilation of the coronary arteries is roughly 4-6 times the resting coronary blood flow. CFR depends on at least 3 factors:
• large and small coronary artery resistance,
• extravascular (ie, myocardial and interstitial) resistance, and
• blood composition.
Myocardial ischemia can result from
• a reduction of coronary blood flow caused by fixed and/or dynamic epicardial coronary artery (ie, conductive vessel) stenosis,
• abnormal constriction or deficient relaxation of coronary microcirculation (ie, resistance vessels), or
• reduced oxygen-carrying capacity of the blood.
Atherosclerosis is the most common cause of epicardial coronary artery stenosis and, hence, angina pectoris. Patients with a fixed coronary atherosclerotic lesion of at least 50% show myocardial ischemia during increased myocardial metabolic demand as the result of a significant reduction in CFR. These patients are not able to increase their coronary blood flow during stress to match the increased myocardial metabolic demand, thus they experience angina. Fixed atherosclerotic lesions of at least 90% almost completely abolish the flow reserve; patients with these lesions may experience angina at rest.
Coronary spasm can also reduce CFR significantly by causing dynamic stenosis of coronary arteries. Prinzmetal angina is defined as resting angina associated with ST-segment elevation caused by focal coronary artery spasm. Although most patients with Prinzmetal angina have underlying fixed coronary lesions, some have angiographically normal coronary arteries. Several mechanisms have been proposed for Prinzmetal angina: focal deficiency of nitric oxide production,[2] hyperinsulinemia, low intracellular magnesium levels, smoking cigarettes, and using cocaine.
Approximately 30% of patients with chest pain referred for cardiac catheterization have normal or minimal atherosclerosis of coronary arteries. A subset of these patients demonstrates reduced CFR that is believed to be caused by functional and structural alterations of small coronary arteries and arterioles (ie, resistance vessels). Under normal conditions, resistance vessels are responsible for as much as 95% of coronary artery resistance, with the remaining 5% being from epicardial coronary arteries (ie, conductive vessels).
The former is not visualized during regular coronary catheterization. Angina due to dysfunction of small coronary arteries and arterioles is called microvascular angina. Several diseases, such as diabetes mellitus, hypertension, and systemic collagen vascular diseases (eg, systemic lupus erythematosus, polyarteritis nodosa), are believed to cause microvascular abnormalities with subsequent reduction in CFR.
The syndrome that includes angina pectoris, ischemialike ST-segment changes and/or myocardial perfusion defects during stress testing, and angiographically normal coronary arteries is referred to as syndrome X. Most patients with this syndrome are postmenopausal women, and they usually have an excellent prognosis.[3] Syndrome X is believed to be caused by microvascular angina. Multiple mechanisms may be responsible for this syndrome, including (1) impaired endothelial dysfunction,[4] (2) increased release of local vasoconstrictors, (3) fibrosis and medial hypertrophy of the microcirculation, (4) abnormal cardiac adrenergic nerve function, and/or (5) estrogen deficiency.[
A number of extravascular forces produced by contraction of adjacent myocardium and intraventricular pressures can influence coronary microcirculation resistance and thus reduce CFR. Extravascular compressive forces are highest in the subendocardium and decrease toward the subepicardium. Left ventricular (LV) hypertrophy together with a higher myocardial oxygen demand (eg, during tachycardia) cause greater susceptibility to ischemia in subendocardial layers.
Myocardial ischemia can also be the result of factors affecting blood composition, such as reduced oxygen-carrying capacity of blood, as is observed with severe anemia (hemoglobin, < 8 g/dL), or elevated levels of carboxyhemoglobin. The latter may be the result of inhalation of carbon monoxide in a closed area or of long-term smoking.
Ambulatory ECG monitoring has shown that silent ischemia is a common phenomenon among patients with established coronary artery disease.
In one study, as many as 75% of episodes of ischemia (defined as transient ST depression of ≥ 1 mm persisting for at least 1 min) occurring in patients with stable angina were clinically silent.
Silent ischemia occurs most frequently in early morning hours and may result in transient myocardial contractile dysfunction (ie, stunning). The exact mechanism(s) for silent ischemia is not known. However, autonomic dysfunction (especially in patients with diabetes), a higher pain threshold in some individuals, and the production of excessive quantities of endorphins are among the more popular hypotheses.
These nerve fibers extend from the first to fourth thoracic spinal nerves, ascending via the spinal cord to the thalamus, and from there to the cerebral cortex.
Studies have shown that adenosine may be the main chemical mediator of anginal pain. During ischemia, ATP is degraded to adenosine, which, after diffusion to the extracellular space, causes arteriolar dilation and anginal pain. Adenosine induces angina mainly by stimulating the A1 receptors in cardiac afferent nerve endings.
For most patients with stable angina, physical examination findings are normal. Diagnosing secondary causes of angina, such as aortic stenosis, is important.
A positive Levine sign (characterized by the patient's fist clenched over the sternum when describing the discomfort) is suggestive of angina pectoris.
Look for physical signs of abnormal lipid metabolism (eg, xanthelasma, xanthoma) or of diffuse atherosclerosis (eg, absence or diminished peripheral pulses, increased light reflexes or arteriovenous nicking upon ophthalmic examination, carotid bruit).
Examination of patients during the angina attack may be more helpful. Useful physical findings include third and/or fourth heart sounds due to LV systolic and/or diastolic dysfunction and mitral regurgitation secondary to papillary muscle dysfunction.
Pain produced by chest wall pressure is usually of chest wall origin.
Metabolic syndrome: This has been characterized by the presence of hyperinsulinemia (fasting glucose level, ≥ 100 mg/dL), abdominal obesity (waist circumference, >40 in for men or >35 in for women), decreased HDL cholesterol levels (< 40 mg/dL for men or < 50 mg/dL for women), hypertriglyceridemia (>150 mg/dL), and hypertension (≥ 130/85 mm Hg). Based on data from the 2000 US census, an estimated 47 million Americans have the metabolic syndrome. Patients with the metabolic syndrome have a 3-fold increased risk for coronary atherosclerosis and stroke compared with those without this syndrome.
Metoprolol (Lopressor, Toprol XL)
Selective beta1-adrenergic receptor blocker that decreases automaticity of contractions. Is lipophilic and penetrates CNS.Atenolol (Tenormin)
Selectively blocks beta-1 receptors with little or no effect on beta-2 receptors. Is hydrophilic and does not penetrate CNS.
Propranolol (Inderal)
Nonselective beta-blocker that is lipophilic (penetrates CNS). Although generally short-acting agent, long-acting preparations also available
Short-acting nitroglycerins
Class Summary
Suitable for immediate relief of exertional or rest angina. Can also be used for prophylaxis several minutes before planned exercise to avoid angina. Reduce myocardial oxygen demand by reduction of LV and arterial pressure, primarily by reducing preload.
Nitroglycerin IV (Nitrostat, Nitro-bid, Nitrol)
Causes relaxation of vascular smooth muscle by stimulating intracellular cyclic GMP production. Result is decrease in BP.
Long-acting nitroglycerins
Class SummaryReduce LV preload and afterload by venous and arterial dilation, which subsequently reduces myocardial oxygen consumption and relieves angina. Also cause dilation of epicardial coronary arteries, which is beneficial in patients with coronary spasm. In addition, nitroglycerin has antithrombotic and antiplatelet effects in patients with angina pectoris. No evidence suggests that nitrates improve survival or slow progression of coronary artery disease.
Isosorbide (Isordil, ISMO)
Relaxes vascular smooth muscle by stimulating intracellular cyclic GMP.Decreases LV pressure
(ie, preload) and arterial resistance (ie, afterload). Reduces cardiac oxygen demand by decreasing LV pressure and dilating arteries.
Ranolazine (Ranexa)
Cardioselective anti-ischemic agent (piperazine derivative) that partially inhibits fatty acid oxidation. Also inhibits late sodium current into myocardial cells and prolongs QTc interval. Indicated for chronic angina unresponsive to other antianginal treatments. Used in combination with amlodipine, beta-blockers, or nitrates.Unlike beta-blockers, calcium channel blockers, and nitrates, does not reduce blood pressure or heart rate. Effect on angina rate or exercise tolerance appears to be smaller in women than in men. Absorption is highly variable but unaffected by food.
About every 25 seconds, an American will have a coronary event, and about every minute someone will die from one. Coronary heart disease (CHD) caused about 1 of every 5 deaths in the United States in 2005. Final 2005 coronary heart disease mortality in 2005 was 445,687 (232,115 males and 213,572 females). On the basis of 2005 mortality rate data, nearly 2,400 Americans die of cardiovascular disease (CVD) each day—an average of 1 death every 37 seconds.
Prognosis of angina
The main adverse outcomes are unstable angina, MI, and sudden death due to arrhythmias.
Annual mortality rate is about 1.4% in patients with angina, no history of MI, a normal resting ECG, and normal BP.
However, women with CAD tend to have a worse prognosis.
Mortality rate is about 7.5% when systolic hypertension is present, 8.4% when the ECG is abnormal, and 12% when both are present.
Type 2 diabetes about doubles the mortality rate for each scenario.
Prognosis worsens with increasing age, increasingly severe anginal symptoms, presence of anatomic lesions, and poor ventricular function. Lesions in the left main coronary artery or proximal left anterior descending artery indicate particularly high risk. Although prognosis correlates with number and severity of coronary arteries affected, prognosis is surprisingly good for patients with stable angina, even those with 3-vessel disease, if ventricular function is normal.
Important prognostic indicators in patients with angina pectoris include LV function, severity and location of atherosclerotic lesions, and response of symptoms to medical treatment.
LV function is the strongest predictor of long-term survival. Elevated LV end-diastolic pressure and volume along with reduced LV ejection fraction ( < 40%) are poor prognostic signs.
Critical lesions of left main and proximal left anterior descending coronary arteries are associated with a greater risk. Mortality rates are also directly associated with the number of epicardial arteries involved.
Unstable angina, recent MI, or both is a sign of atherosclerotic plaque instability, which is a strong predictor of increased risk of short-term coronary events.
A number of signs during noninvasive testing are predictive of a higher risk of coronary events, including ST-segment depression of more than 2 mm at a low workload, ST-segment depression that persists for more than 5 minutes after termination of exercise, and failure of blood pressure to rise or an actual drop in blood pressure.
Patients who continue to smoke after an MI have a 22-47% increased risk of reinfarction and death.
In general, Prinzmetal angina and syndrome X are associated with excellent long-term prognoses.
Prognosis
Within one year of having a first myocardial infarction, it has been reported that 25% of men and 38% of women will die.Within six years of having a first myocardial infarction, 18% of men and 35% of women will have another myocardial infarction, 22% of men and 46% of women will have heart failure, and 7% of men and 6% of women will have sudden death.
The patient's outcome after acute myocardial infarction has improved over recent years. Between 1999 and 2006, in patients with ST elevation myocardial infarction there was a fall in in-hospital deaths, congestive heart failure, and pulmonary oedema, and a fall in myocardial infarction diagnosed more than 24 hours after presentation to hospital or recurrent myocardial infarction.
Between hospital discharge and a time frame of six months, there was a reduction in the rate of myocardial infarction and stroke. In patients with non-ST elevation acute coronary syndrome, there was also a reduction in in-hospital deaths, congestive heart failure, and pulmonary oedema, and myocardial infarction diagnosed more than 24 hours or recurrent myocardial infarction. Between hospital discharge and a time frame of six months, there was a reduction in the rate of death and stroke. In both groups, there was an increase in evidence based interventions during the time period.
Stress testing: More specific tests include stress testing with ECG or with myocardial imaging (eg, echocardiography, radionuclide imaging) and coronary angiography. Further testing is needed to confirm the diagnosis, evaluate disease severity, determine appropriate exercise levels for the patient, and help predict prognosis.
Noninvasive tests are considered first. For coronary artery disease (CAD), the most accurate are stress echocardiography and myocardial perfusion imaging with single-photon emission CT (SPECT) or PET. However, these tests are more expensive than simple stress testing with ECG.
If a patient has a normal resting ECG and can exercise, exercise stress testing with ECG is done. In men with chest discomfort suggesting angina, stress ECG testing has a specificity of 70%; sensitivity is 90%. Sensitivity is similar in women, but specificity is lower, particularly in women < 55 (< 70%).
women are more likely than men to have an abnormal resting ECG when CAD is present (32% vs 23%).
Although sensitivity is reasonably high, exercise ECG can miss severe CAD (even left main or 3-vessel disease).
In patients with atypical symptoms, a negative stress ECG usually rules out angina pectoris and CAD; a positive result may or may not represent coronary ischemia and indicates need for further testing.
When the resting ECG is abnormal, false-positive ST-segment shifts are common on the stress ECG, so patients should have stress testing with myocardial imaging.
Exercise or pharmacologic stress (eg, with dobutamine
or dipyridamole infusion) may be used. The choice of imaging technique depends on institutional availability and expertise. Imaging tests can help assess LV function and response to stress; identify areas of ischemia, infarction, and viable tissue; and determine the site and extent of myocardium at risk.Stress echocardiography can also detect ischemia-induced mitral regurgitation.
Angiography: Coronary angiography is the standard for diagnosing CAD but is not always necessary to confirm the diagnosis. It is indicated primarily to locate and assess severity of coronary artery lesions when revascularization (percutaneous intervention [PCI] or coronary artery bypass grafting [CABG]) is being considered.
Angiography may also be indicated when knowledge of coronary anatomy is necessary to advise about work or lifestyle needs (eg, discontinuing job or sports activities). Obstruction is assumed to be physiologically significant when the luminal diameter is reduced > 70%.
This reduction correlates well with the presence of angina pectoris unless spasm or thrombosis is superimposed.
Intravascular ultrasonography provides images of coronary artery structure. An ultrasound probe on the tip of a catheter is inserted in the coronary arteries during angiography. This test can provide more information about coronary anatomy than other tests; it is indicated when the nature of lesions is unclear or when apparent disease severity does not match symptom severity. Used with angioplasty, it can help ensure optimal placement of stents.
Imaging: Electron beam CT can detect the amount of Ca present in coronary artery plaque. The Ca score (from 1 to 100) is roughly proportional to the risk of subsequent coronary events. However, because Ca may be present in the absence of significant stenosis, the score does not correlate well with the need for angioplasty or CABG. Thus, the American Heart Association recommends that screening with electron beam CT should be done only for select groups of patients and is most valuable when combined with historical and clinical data to estimate risk of death or nonfatal MI.
These groups may include asymptomatic patients with an intermediate Framingham 10-yr risk estimate of 10 to 20% and symptomatic patients with equivocal stress test results.
Multidetector row CT (MDRCT) coronary angiography can accurately identify coronary stenosis and has a number of advantages. The test is noninvasive, can exclude coronary stenosis with high accuracy, can establish stent or bypass graft patency, can visualize cardiac and coronary venous anatomy, and can assess calcified and noncalcified plaque burden.
However, radiation exposure is significant, and the test is not suitable for patients with a heart rate of > 65 beats/min, those with irregular heart beats, and pregnant women.
Patients must also be able to hold their breath for 15 to 20 sec, 3 to 4 times during the study.
Evolving indications for MDRCT coronary angiography include:
Asymptomatic high-risk patients or patients with atypical or typical angina who have inconclusive exercise stress test results, cannot undergo exercise stress testing, or need to undergo major noncardiac surgeryPatients in whom invasive coronary angiography was unable to locate a major coronary artery or graft .
Cardiac MRI has become invaluable in evaluating many cardiac and great vessel abnormalities.
It may be used to evaluate CAD by several techniques, which enable direct visualization of coronary stenosis, assessment of flow in the coronary arteries, evaluation of myocardial perfusion and metabolism, evaluation of wall motion abnormalities during stress, and assessment of infracted myocardium vs viable myocardium.
Current indications for cardiac MRI include evaluation of cardiac structure and function, assessment of myocardial viability, and possibly diagnosis and risk assessment of patients with either known or suspected CAD.
Pemberton's sign
Pemberton's sign is the development of facial flushing,[1] distended neck and head superficial veins, inspiratory stridor and elevation of the jugular venous pressure (JVP) upon raising of the patient's both arms above his/her head simultaneously, as high as possible (Pemberton's maneuver).It is named for Dr. Hugh Pemberton, who characterized it in 1946.Causes
A positive Pemberton's sign is a sign of superior vena cava syndrome, possibly from a mass in the mediastinum, such as a tumor[or goiter[4] (thoracic inlet obstruction due to retrosternal goitre or mass).
Apical lung cancers often cause a positive Pemberton's sign and a high index of suspicion should be maintained in patients with symptoms of dyspnea and facial plethora with an extensive smoking history.
What time window do you have to give thrombolysis for pulmonary embolism?
The time frame for thrombolysis for pulmonary embolism is different to that for myocardial infarction. Trials have delivered thrombolysis up to seven days after the embolic event and demonstrated improvements in pulmonary perfusion. However delivering therapy as early as possible makes good sense - and is recommended by the British Thoracic Society guidelines. Indeed 75% of those who die from pulmonary embolism do so within one hour of the event. For patients with no cardiovascular compromise, thrombolysis is not advisable
How should you give thrombolytics?
Despite the theoretical advantages of higher local concentration at the clot site, the delivery of thrombolysis via pulmonary artery catheter offers no advantage in terms of mortality, morbidity, or haemorrhage over peripheral administration and carries the risks of a more invasive procedure (according to the results of a single trial).Bolus therapy may be expected to produce more rapid thrombolysis with improved outcome but two trials found this method of administration offered no advantage over infusion regimens.
What are the complications of thrombolysis?
The major complication of thrombolysis is haemorrhage, although allergy, hypotension, fever, nausea, and vomiting may occur.The overall risk of haemorrhage with thrombolysis is reported as
6-20%, with no significant differences between the alternative agents.
The most feared bleeding complication is intracerebral haemorrhage, which has a reported incidence of 0.6-3%.
The risk factors associated with intracranial bleeding are:
• Increasing age (0.4% at <65 years and 2.1% at >75 years)
• Increasing dose of thrombolytic
• Chronic hypertension
• Female sex
• Low body mass (with weight <70 kg being associated with a fourfold increase)
• Pulmonary catheterisation.
The risk of bleeding largely defines the contraindications to thrombolysis.
These relative contraindications are
• active or recent (within six weeks) bleeding
• intracranial disease,
• trauma, visceral biopsy,
• surgery, or
• gastrointestinal bleed,
• haemorrhagic disorder,
• hepatic or renal failure,
• pregnancy, puncture of a non-compressable vessel,
• pericarditis.
Typical arteriographic findings of thromboangiitis obliterans:
Non-invasive Doppler pulse volume andwaveform analysis should confirm the diagnosis of arterial insufficiency. Angiography is the most useful aid in diagnosis. The occlusive thrombus seen on angiography differs from that seen in other vasculitides, because of the high inflammatory cell infiltrate and relative sparing of the vessel wall.
Furthermore, severe infrapopliteal disease in
the absence of proximal arterial involvement does notusually occur in atherosclerosis but is typical in Buerger’s
disease. The arteriographic findings that most characterise Buerger’s disease include no evidence of atherosclerosis; no source for thromboembolism; involvement of small sized and medium sized vessels such as plantar, tibial, peroneal, radial, and ulnar arteries; segmental occlusion with disease interspersed between normal appearing segments (skip lesions); and collateralisation around areas of occlusion (corkscrew collaterals). Avoid biopsy unless it is taken from amputated tissue because of the risk of producing a non-healing wound.
Exclusion of autoimmune disease, thrombophilia, diabetes, and proximal embolic source: The purpose of laboratory investigations is to exclude other entities that cause occlusive vascular disease such as diabetes, vasculitides, and thrombophilias. Perform a full blood count, hypercoagulability screen, urinalysis, renal function tests, and immunological panel. Fasting glucose, liver enzymes, and acute phase reactants should also be measured.
What single management provides the best outcome and reduces the need for further amputations?
Short answer
Complete cessation of smoking.
Long answer
The treatment of Buerger’s disease aims to:
• Improve arterial flow to the limb
• Alleviate ischaemic pain
• Treat concomitant infections
• Treat thrombophlebitis
• Improve wound healing by local treatment.
The prognosis of Buerger’s disease is directly related to tobacco use, and by far the greatest priority is smoking cessation.
Complete smoking cessation is essential because even a few cigarettes a day can cause disease progression.
A longitudinal study of 120 patients with Buerger’s disease showed that the incidence of amputation in patients who stopped smoking was only 6% compared with 43% in those who continued to smoke.
Vasodilators are generally not effective, although iloprost, ((astable prostacyclin analogue)), may be useful. A prospective randomised double blind trial noted an 85% improvement in pain and trophic changes in those treated with iloprost, with a
reduction in amputation rate at six months’ follow-up.
More recently, a pilotstudy found immunoadsorption treatment to be effective in patients with Buerger’s disease. A single anti-immunoglobulin immunoadsorption course over five consecutive days was shown to improve pain and ulceration at one month.
Although it is important to improve the local symptoms of superficial thrombophlebitis, treatment is largely aimed at preventing venousthromboembolism.
Recommended therapeutic options include oral non-steroidal anti-inflammatory drugs and low molecular weight heparin.
Both treatments significantly reduce the incidence and recurrence of superficial thrombophlebitis by 70% when compared with placebo.
Further research is needed, however, to determine the optimal dose and duration of treatment.
Surgical revascularisation is not an option in most cases owing to poor run-off vessels. It should be considered only in those patients who need immediate amputation and who have a target vessel.
Patient outcome
The patient was given advice and support to help him stop smoking. An iloprost infusion wastrialled but had limited effect.Unfortunately, after regular review in the podiatry and diabetic foot clinic and a prolonged course of antibiotics he developed ulceration of multiple toes, which required multiple phalanx amputation. He has since stopped smoking and has had no further amputations.
Patients on simvastatin should avoid grapefruit juice
This is because grapefruit juice has been shown to increase the concentration of some CYP3A4 substrates such as simvastatin; even modest quantities of grapefruit juice can lead to a large increase in the concentration of simvastatin, thereby increasing the risk of rhabdomyolysisPatients on warfarin should avoid cranberry juice Cranberry juice can cause the international normalised ratio to rise through an unknown pharmacodynamic interaction and so may cause bleeding in patients on warfarin.
It is often forgotten that erythrocyte sedimentation rate (ESR) can be adapted for age and sex.
If Miller and colleagues’ simple formula for maximum normal ESR (for men: age in years/2; for women: (age in years+10)/2) is used, the 72 year old man in Hamilton and colleagues’ article would have been allowed to have an ESR of up to 36 without it being regarded as raised.
This easy manoeuvre greatly increases the positive predictive value of ESR testing and makes ESR far more useful than plasma viscosity in clinical practice.
BMJ 2012
It is important to have the proper ratio of omega-3 and omega-6 (another essential fatty acid) in the diet. Omega-3 fatty acids help reduce inflammation, and most omega-6 fatty acids tend to promote inflammation. The typical American diet tends to contain 14 - 25 times more omega-6 fatty acids than omega-3 fatty acids, which many nutritionally oriented physicians consider to be way too high on the omega-6 side.
The Mediterranean diet, on the other hand, has a healthier balance between omega-3 and omega-6 fatty acids. Many studies have shown that people who follow this diet are less likely to develop heart disease. The Mediterranean diet emphasizes foods rich in
omega-3 fatty acids, including whole grains, fresh fruits and vegetables, fish, olive oil, garlic, as well as moderate wine consumption.
What is the n-6/n-3 ratio?
The ratio is the ratio of grams omega-6 fatty acids to grams omega-3 fatty acids ina food. The ratio is helpful to use when choosing foods because it is important not
to eat too many more omega-6 fatty acids than omega-3 fatty acids.
The current recommendation is 4 grams or less of omega-6 fatty acid for every 1 gram of omega-3 fatty acids .
What is the n-6/n-3 ratio?
The ratio is the ratio of grams omega-6 fatty acids to grams omega-3 fatty acids ina food. The ratio is helpful to use when choosing foods because it is important not
to eat too many more omega-6 fatty acids than omega-3 fatty acids. The current
recommendation is 4 grams or less of omega-6 fatty acid for every 1 gram of
omega-3 fatty acid. Choose foods whose n-6/n-3 ration is less than 4.
Glycemic Control in Type 2 Diabetes Mellitus
Intensive glycemic control reduces the risk of microvascular complications of type 2 diabetes, but the effect of strict glycemic control on the risk of macrovascular disease (especially in well-established type 2 diabetes) is less certain.Psychosocial factors (e.g., motivation and capacity for self-care) and clinical factors (e.g., age, presence or absence of coexisting conditions, and presence or absence of a tendency toward hypoglycemia) should be considered in setting a target range of glycated hemoglobin for an individual patient.
NEJM april 5, 2012
A near-normal glycemic target range (6.0 to 6.5%), if implemented safely, could be considered for otherwise healthy patients with recently diagnosed type 2 diabetes and a long life expectancy; more relaxed goals for the glycated hemoglobin level may be preferable in older patients with long-standing type 2 diabetes and cardiovascular disease.
Lifestyle modification and metformin are recommended as initial therapies for most patients with type 2 diabetes.
Several therapeutic agents are available when therapy in addition to metformin is needed to control glycemia, but evidence is lacking to support the choice of any one agent over another. Decisions should take into account cost, side effects, and long-term safety and effects on complications of diabetes.
There was no significant difference between off-pump and on-pump CABG with respect to the 30-day rate of death, myocardial infarction, stroke, or renal failure requiring dialysis. The use of off-pump CABG resulted in reduced rates of transfusion, reoperation for perioperative bleeding, respiratory complications, and acute kidney injury but also resulted in an increased risk of early revascularization.
NEJM april 19, 2012
Which disorders may be manifested by paresthesias and sensory ataxic gait?
The combination of paresthesias and sensory ataxic gait is typically caused by dysfunction of the dorsal columns, and may be caused by syphilis, tickborne illnesses, human immunodeficiency virus infection, vitamin deficiencies including deficiencies of vitamin B12, folate and vitamin E, paraneoplastic syndromes, and autoimmune diseases.Although they are less likely, multiple sclerosis and amyloidosis should also be considered as well.
What is the differential diagnosis of a macrocytic anemia?
The different causes can be classified as arising from immature or stress cells (e.g., reticulocytosis, aplasias, and Fanconi’s anemia), abnormal DNA metabolism (e.g., vitamin B12 and folate deficiency and drugs or toxins), abnormal lipid metabolism (e.g., liver disease and hypothyroidism), a bone marrow disorder (e.g., myelodysplastic syndromes, leukemia, and congenital abnormalities), and anunknown mechanism (e.g., alcoholism and plasma-cell dyscrasias).
Morning Report Questions
Q. What is the classic presentation of vitamin B12 deficiency?A. The classic triad of clinical findings associated with vitamin B12 deficiency is weakness and fatigue, glossitis, and paresthesias. In addition, other clinical findings include anemia, clumsiness and unsteady gait, nonspecific gastrointestinal symptoms, and weight loss.
Q. What are the laboratory findings associated with pernicious anemia?
A. Classic findings associated with pernicious anemia include atrophic body gastritis and intrinsic factor deficiency. A highly elevated fasting gastrin level (504 pg per milliliter; reference range, <100 pg per milliliter) and a reduced pepsinogen I level (<24.6 ng per milliliter; reference range, 28 to 100 ng per milliliter) are consistent with atrophic body gastritis. The detection of antibodies to intrinsic factor is useful in making the diagnosis of pernicious anemia.In approximately 40 to 60% of patients with pernicious anemia, positivity for anti-intrinsic factor antibodies is present and provides evidence to support the diagnosis, with a specificity approaching 100%.
The homocysteine level is elevated in both anemia due to vitamin B12 deficiency and anemia due to folate deficiency.
In contrast, the methylmalonic acid level is elevated only in vitamin B12 deficiency and is normal in folate deficiency."
Individuals with the following characteristics are at heightened risk with tight glycemic control:
• History of severe hypoglycemia (inability to treat without assistance): any episodes within the past year and/or more than 2 episodes ever
• Hypoglycemia unawareness
• Advanced cardiovascular or cerebrovascular disease
• Autonomic neuropathy (especially cardiac)
• Comorbidities/medications that impair the detection of hypoglycemia (e.g., central nervous system [CNS]-acting drugs, alteration in mental status)
• Lack of mobility or lives alone